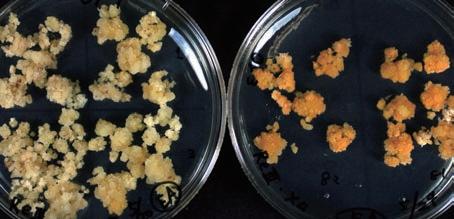

Guide Book 2024 You, Unlimited
Contents
龍谷大学のキャリアサポート

龍谷大学で学ぶ意義とは? 02 Topics 04 龍谷大学の社会貢献 地域連携活動 10 社会貢献活動 .................................................. 12 留学生支援・ボランティア活動 14 龍谷大学の研究 研究活動 16 龍谷大学の教育 学部・学科・課程・専攻 ............................... 28 教養教育/外国語教育 30 大宮キャンパス 32 ・心理学部 36 ・文学部 38 深草キャンパス........................................... 40 ・経済学部 44 ・経営学部 46 ・法学部 ...................................................... 48 ・政策学部 50 学部共通コース 52 ・国際学部 ................................................... 54 ・短期大学部 56 瀬田キャンパス 58 ・先端理工学部 62 社会学部 64 ・農学部 ...................................................... 66 龍谷大学の国際交流 国際交流・留学 ........................................... 70
キャリア支援スケジュール 78 RYUKOKUキャリア・スタートプログラム 81 進路・就職データ ........................................ 82 専門資格・教員免許状等 84 龍谷大学の課外活動 体育系課外活動 88 文化系課外活動 90 その他 学食&カフェ 92 学費等について/奨学金制度 94 学生寮 96 その他の施設 .............................................. 98 Access Guide 100
世界は驚くべきスピードでその姿を変え、 将来の予測が難しい時代となっています。
いま必要なことは、「学び」を深めること。 「つながり」に目覚めること。
龍谷大学は「まごころある市民」を育んでいきます。
自らを見つめ直し、他者への思いやりを発動する。
自分だけでなく他の誰かの安らぎのために行動する。 それが、私たちが大切にしている 「自省利他」であり、「まごころ」です。
その心があれば、激しい変化の中でも本質を見極め、 変革への一歩を踏み出すことができるはず。
探究心が沸き上がる喜びを原動力に、
より良い社会を構築するために。
新しい価値を創造するために。
私たちは、大学を「心」と「知」と「行動」の拠点として、 地球規模で広がる課題に立ち向かいます。

1639年の創立以来、貫いてきた進取の精神、
そして日々積み上げる学びをもとに、様々な人と手を携えながら、 誠実に地域や社会の発展に力を尽くしていきます。
豊かな多様性の中で、心と心がつながる。人と人が支え合う。 その先に、社会の新しい可能性が生まれていく。
龍谷大学が動く。未来が輝く。
You, Unlimited

Ryukoku University 2024 02
龍谷大学で学ぶ意義とは? 龍谷大学 学長 入澤 崇 Takashi Irisawa
Q龍谷大学は、どんな大学ですか?
龍谷大学の始まりは、1639(寛永16)年に西本願寺境内に設けられた教育施設「学寮」です。380年 以上の伝統をもち、日本で一番長く教育・研究活動を行ってきました。伝統というと古めかしく感じ られるかもしれませんが、社会の現実に常に向き合うことをしなければ伝統は続きません。研究の 高度化推進事業、仏教系大学初の理工学部創設ならびに農学部創設など、「先進性」や「進取」を尊 ぶ気風は、本学の大きな特長です。
龍谷大学でどんな力を身につけてほしいですか? Q
多くの課題が山積みとなっている現代社会に立ち向かうには、「生きる指針」と「考える力」を備える 必要があります。しっかりと現実を直視し、未来を切り拓けるように、「学びの姿勢」を身につけてほ しいと思います。自分の可能性を開花させるものは何か? 自分の可能性を阻むものは何なのか? など を見極めながら身につける学びの姿勢は、「生きるうえで何が大切か?」を考える力にもつながります。 龍谷大学は建学の精神に基づき、「真実を求め、真実に生き、真実を顕かにする」ことのできる人間を 育成します。それを実現するためには学生一人ひとりが自分本位の生き方を省みて、自己中心的なあ り方から社会の利益をめざす生き方へと変わっていくことが必要です。自分は肝心なことを何も知ら なかったと気づいたとき、真の学びがスタートします。本学での学びをとおして、助け合うこと、支え 合うことの大切さに目覚めていくと「まごころある市民」へと成長していくのです。

龍谷大学の教育がめざす未来とは? Q
建学の精神
龍谷大学の「建学の精神」は「浄土真宗の精神」です。浄土真宗の精神とは、生きとし生けるもの全てを、迷いから悟 りへ転換させたいという阿弥陀仏の誓願に他なりません。迷いとは、自己中心的な見方によって、真実を知らずに自 ら苦しみをつくり出しているあり方です。悟りとは自己中心性を離れ、ありのままのすがたをありのままに見ること のできる真実の安らぎのあり方です。阿弥陀仏の願いに照らされ、自らの自己中心性が顕わにされることにおいて、 初めて自己の思想・観点・価値観等を絶対視する硬直した視点から解放され、広く柔らかな視野を獲得することがで きるのです。本学は、阿弥陀仏の願いに生かされ、真実の道を歩まれた親鸞聖人の生き方に学び、「真実を求め、真実 に生き、真実を顕かにする」ことのできる人間を育成します。このことを実現する心として以下5項目にまとめてい ます。これらはみな、建学の精神あってこその心であり、生き方です。
● すべてのいのちを大切にする「平等」の心
● 真実を求め真実に生きる「自立」の心
● 常にわが身をかえりみる「内省」の心
● 生かされていることへの「感謝」の心
● 人類の対話と共存を願う「平和」の心
Ryukoku University 2024 03
Topics 1 2025年4月
龍谷大学社会学部は 深草キャンパス(京都市) へ移転します。
龍谷大学社会学部への入学を 希望されているみなさまへ
[2024年4月入学生のみなさま] 現行の3学科体制のまま、2年生から深草キャンパスに通学します。
[2025年4月以降入学生のみなさま] 移転と同時に3学科体制から1学科となる予定であり、1年生から深草キャンパスに通学します。

1 年次 2 年次 3 年次 4 年次 2025年 4月以降 入学生 深草キャンパス
1 年次 2 年次 3 年次 4 年次 2024年 4月入学生 深草キャンパス 瀬田キャンパス
Ryukoku University 2024 04

Ryukoku University 2024 05



紫朋館・紫陽館跡地新棟 体育館北側新棟 深草キャンパス南エリア全景 Ryukoku University 2024 06
Topics 2 2025年、 深草キャンパスが 生まれ変わります(2023年構想中)
深草キャンパスでは多様性を象徴する 「深草の森」をコンセプトに施設の整備を行います。
学生、教職員、地域社会、そしてすべての市民に開かれた キャンパスをめざします。



2号館北側新棟 紫光館別館跡地新棟
Ryukoku University 2024 07
Less Me

Ryukoku University 2024 08
More We
龍谷大学の社会貢献
「地域・社会・世界」の平和のために、様々な人や組織と連携しながら、 社会にインパクトを生み出していく。
それが、龍谷大学の社会貢献のあり方です。
多様性を尊重し、人々とともに目の前で起きている課題と向き合い、
ひたむきに努力し逆境に挑む。他者を思う共感力を原動力として、
誰一人取り残すことのない社会の実現に寄与していきます。
Ryukoku University 2024 09
余剰・廃棄衣料で 雑貨をつくり
循環型の社会へ貢献

01
Masahiro Fujita
Ryukoku University 2024 10
Regional Contribution

地域連携活動
今までにない循環の仕組みづくりで社会に貢献したい
私が学生ベンチャー団体「 京 きょうゆ
結 える」を立ち上げたきっかけは、2年生のときに、鴨川の川べり でたくさん溜まった廃棄物を見たことです。ゴミ拾いは大切なことですが、根本的にゴミを減ら すことが必要ではないか。そんな気づきから活動を始めました。今では、廃棄・余剰資源を活用 した素材開発と、まちづくりをテーマにした取り組みを行っています。今回の「サステナブル ロ ハスフェスタ」(イオンモール京都桂川)で販売した商品 は、余剰・廃棄衣料を細かく断裁した後にアップサイクル した雑貨です。すでに事業化しており、原料になる素材提 供や粉砕に協力してくださる企業などとの連携のうえで 成り立っています。地域、住民、行政がつながる地域循環 を生み出す事業の一つです。私たちは「日常に彩りの循環 を」をミッションに、日常で廃棄問題を実感できる仕組み づくりによる社会貢献をめざしています。循環型の未来 社会をつくるには、現場はもちろん、法律などさまざまな ことが関わります。単に事業を進めるだけでなく、全体を 見通せる活動を実践したいと考えています。

Other Topics
地域資源と知的資源を双方向サイクルで活用する 社会連携活動拠点「REC」 ※

学内外の諸機関と積極的に連携し、真に持続可能な社会の実現をめ ざす価値創造を通じ、地域社会の発展のために貢献するプラット フォームとなること、既存の慣習にとらわれることなく、社会変革 を担う人間を育むことを基本方針としています。

※REC:Ryukoku Extension Center

ビジネスプランコンテスト「プレゼン龍(ドラゴン)」 で学生ベンチャーを発掘育成
「プレゼン龍(ドラゴン)」は、チャレンジ精神や創造性に富む人 材を輩出する学生ベンチャー育成事業の一環として開催。本学 の学生は誰でも出場可能。ビジネスプランをプレゼンテーショ ン形式で競い、グランプリをめざします。
桃山学院高等学校 出身)
藤田 政広 さん 経営学部 経営学科 4年生(大阪府
Ryukoku University 2024 11
Philanthropy
社会貢献活動
クラウドファンディングで立ち上げたアパレルブランドで、
社会課題の改善に参画するハードルを下げる
宮田 知己 さん BeComme(ビーコム)代表(国際学部 国際文化学科 2022年3月卒業)
社会課題の解決には個人、サークル、NPO法人など、多様な形で多くの人が取り組んでいます。しかし、こ うした課題はメディアでクローズアップされてもその時限りになりがちです。私は、幼い頃から犬・猫の殺 処分をなんとかしたいと考えており、特に学生時代には「誰もが継続的にこの課題に取り組める方法はな いか?」といろいろと模索しました。そうしたなかで、身近な衣料品の購入が課題解決に貢献できる仕組み
があればよいのではと考え、クラウドファンディングを活用してアパレルブランド“BeComme”を立ち上 げました。“BeComme”で取り扱う商品は誰もが購入しやすいように靴下を選び、その収益で犬・猫の殺処 分の課題解決を支援しています。人は誰しも社会課題に関心を寄せています。しかしながら、ボランティア に参加したり、募金をしたりといった直接的な活動はなかなか容易ではありません。ですが、靴下の購入な らどう感じるでしょうか。「私にもできる社会貢献!」と、参画のハードルが下がるのではないでしょうか。 “BeComme”は人と社会課題をつなげて、その改善に向かうモデ ルとして誕生したプロジェクトブランドで、購入者は、社会課題 の解決に間接的に参加します。“BeComme”という存在が、多く の方々にとって、犬・猫の殺処分の問題に関心をもつための架け 橋になればと思っています。これからもブランドを通じて、社会 課題を解決したいという多くの願いをカタチにするつもりです。



Other Topics
在学中に起業し、旺盛な意欲と利他精神で 社会課題の解決に挑む
龍谷大学は、社会課題の解決に挑む「ソーシャルビジネス」の起 業家を数多く輩出しています。その多くが在学中に課題を発見 し、その後、起業して活躍。『株式会社RE-SOCIAL』は、獣害被 害対策として鹿や猪が殺処分されているという課題を解決すべ く、学生が在学中に起業し、ジビエ処理加工から販売・流通を手 掛け、循環型社会の実現をめざしています。
革新的な仕組みで「アートのある暮らし」を届け より豊かでクリエイティブな世界をつくる 龍谷大学の卒業生が2017年に創業した株式会社Casieは、絵 画を貸し出すサブスクリプションサービスという新ビジネス を展開しています。ユーザーは一点モノの原画をリーズナブ ルな価格で自宅に飾れ、アーティストは作品発表の機会と報 酬を得られる仕組みが、社会を文化的に豊かにする流れを生 み出しています。

Ryukoku University 2024 12
犬・猫の殺処分問題
改善に取り組む アパレルブランド

02
Ryukoku University 2024 13
Tomoki Miyata

03
Ryukoku University 2024 14
Kurumi Takamatsu
留学生の生活を 学内外でサポート
Volunteering
留学生支援・ボランティア活動
留学生との交流で得た気づきを行動に移し 誰もが安心して暮らせる社会につなげる
高松 来美 さん 経済学部 現代経済学科4年生(大阪府 プール学院高等学校出身)
高校、大学と2度の留学を経験した私にとって、ウクライナ人留学生を支援するサポートメンバーの募 集は願ってもない機会でした。自分自身も感じていた留学生の不安に寄り添ったサポートができればと 考えていたからです。この活動は自由度が高いのが特徴で、サポーターはそれぞれの方法で担当するウ クライナ人留学生をサポートします。私は、信頼関係を築く手段としてSNSで連絡を取り合ったり、一 緒にランチを食べたりして少しずつ距離を縮めました。日本の寺院に興味があると知り京都のお寺を 案内したときは、とても喜んでもらえました。共に過ごす時間が増えるにつれ、私自身も新たな気づき を得ています。例えば、学内の食堂にはヴィーガン向けやムスリム対応のメニューがないことに気づき ました。世界中から集まる留学生が大学に馴染み、不自由のない学生生活を送るには、そういった海外 の文化や風習に配慮したきめ細やかな支援も必要ではないでしょ うか。今すぐには実現しなくても私の提案をきっかけに、いつか本 学にも多様なバックグラウンドをもつ学生向けのメニューが登場 するかもしれません。小さな発見を行動に移し、誰もが安心して過 ごせる環境をつくっていきたいです。


Other Topics
学生スタッフ約100名も活躍
ボランティア・NPO活動センターの取り組み
本学学生や教職員のボランティア活動を促進するため、ボラン ティアを募集している地域団体・施設と参加したい学生・教職 員を“つなぐ”役割をしています。センターでは約100名の学生 スタッフも活動し、職員とともにボランティアのコーディネー トや企画運営を担っています。
伏見区深草をフィールドにした 放置竹林整備と竹チップづくりの活動
『京都 風 かざみどり 緑 』は、深草地域の竹林保全に取り組んでいます。毎年

11 月に伐採した放置竹林の竹を粉砕して竹チップをつくり、農地 へ撒く作業を、一般参加者を募って実施。日本全国で深刻化する 放置竹林問題に学生が一緒に取り組むことで、地域の方々の関心 を集め、次世代へとバトンを引き継ぐきっかけをつくっています。

Ryukoku University 2024 15
[研究テーマ]
インタラクションデザイン


先端理工学部 電子情報通信課程
酒田 信親 准教授
スマホのアプリなどの情報サービスは、多くの人が扱いやすいように設計さ れている反面、まだ標準化されていない規格や個々人の特性に応えるまでに は設計されていません。その課題を解決すべく、私はバーチャルリアリティ (VR)や拡張現実感(AR)を使い、人間中心のインタフェースを模索してい ます。特に五感に働きかけるインタフェースNUI(Natural User Interface) に着目し、より自然な動作で直感的に操作できるインタラクションデザイン を追究しています。カメラ付きヘッドマウントディスプレイ(HMD)を媒体 として、個人の嗜好にあわせて視覚的世界を提供できるシステムの構築に取 り組んでいます。実験で新しい感覚を覚えた被験者が感動する様子を目の当 たりにできるのも、この研究の醍醐味といえるでしょう。
More Fo More Cu
Ryukoku University 2024 16
VR(仮想現実)とAR(拡張現実)を応用した

より快適なインタフェースの創出
cus riosity
龍谷大学の研究
新たな知と価値を創造するために、「心・知・行動」の 拠点として、地域や世界の課題に対峙し、問い続ける。 それが、龍谷大学の研究のあり方です。
これまでの社会のありようや私たちの行動を省み、 先端的な研究や学際的連携による知の集約のもと、
世界の人々と協力して困難な課題に立ち向かう。
その姿勢と行動が、未来の可能性を切り拓いていきます。
Ryukoku University 2024 17

Ryukoku University 2024 18
[研究テーマ] 生理心理学

心理学部 心理学科
藤原 直仁 教授
誰もがあるとは思っているものの、脳や心臓といった臓器のように形としてみ ることができない「こころ」。そんな「こころ」とは何かの解明を目的とする心 理学が、現在のような独立した学問となったのは1879年のことといわれてお り、決して長い歴史をもつわけではありません。それゆえに「こころ」は 、“ブ ラックボックス” のように未解明な点が多いのも事実です。私が専門とする「生 理心理学」では、生理学的指標を応用して「こころ」の動きを分析します。心拍 の変動などから「こころ」の動きを明らかにしようとする「ポリグラフ(うそ 発見器)」も、その一例です。近年では、脳波を分析して「こころ」の動きを可 視化する研究も進んでいます。医学や工学分野との学際的研究や、障がいのあ るこどもたちの治療教育を視野に入れた教育分野での研究も展開されており、 生理心理学は社会のあらゆる事象と関わり深い学問だといえます。

[注意]

私たちは、大勢の人のなかで特定の人の声に「注意」して話ができます(カクテ ルパーティー効果)。事象関連電位(脳波の一種)という指標を用いると、模式図 に矢印で示したように(2つの波形の違いから)、「注意」の有無を可視化できます。
[認知]
私たちは、日常生活でさまざま音のなかから必要な音を聞きわけています(認知)。 事象関連電位(脳波の一種)という指標を用いると、模式図に矢印で示したように (2つの波形の違いから)、2種類の音を聞き分けていることを可視化できます。
生理学的手法を用いて 複雑な「こころ」の動きにアプローチ
Ryukoku University 2024 19
ゲノム編集技術で植物の遺伝子を改変し 「農」と「食」の未来を切り拓く

ゲノム編集とは、ATGC の4 文字からなるDNAの塩基配列(文章)を改変す る技術です。突然変異により優良な遺伝子を誘発し、交配により有用遺伝子 を集積する従来の品種改良とは異なり、目的の遺伝子に狙いを定めて改変 できるため、昨今注目を集めています。すでにゲノム編集技術を用いて品種 改良されたGABA の豊富なトマトが市場にも出回っていて、私自身もトリ プトファンやオレイン酸を多く含むお米や、除草剤に高レベルの耐性を有 するイネの開発に成功しました。地球温暖化や異常気象による影響が深刻 化する農業において、今後ますます、ゲノム編集技術による植物の品種改良 が求められていくでしょう。しかしまだ現在の技術では、DNA の塩基配列 を自由自在に編集できるまでには至っておらず、その効率も満足できるも のではありません。未来の農業や食に貢献できるよう、標的遺伝子を設計通 り、かつ効率的に改変する技術の開発を進めていきます。
β-カロテンを蓄積するカリフラワーのオレンジ遺伝子の機能を参考に、イネ の相同遺伝子をゲノム編集で改変し、イネの培養細胞にβ-カロテンを蓄積さ せることに成功。今後は可食部(お米)にβ-カロテンを蓄積させていきたい。

農学部 生命科学科 土岐 精一 教授
[研究テーマ] 植物における精密ゲノム編集技術の開発
Ryukoku University 2024 20

Ryukoku University 2024 21
手軽にできる運動で心身を健やかに 人生100年時代の健康寿命を延伸

[研究テーマ]
健康なまちづくりプロジェクト
社会学部 コミュニティマネジメント学科
井上 辰樹 教授
健康科学の見地から、運動でまちを元気にする活動に取り組んでいます。守 山市と包括協定を締結、推進している「健康なまちづくりプロジェクト」に は、社会学部の学生が多数参加し、体力測定やストックウォーキング教室な どを開いて、同市に住む高齢者の生活習慣病予防や運動促進に努めていま す。病気とは無縁と考えている若い学生たちの健康意識を高めることも、こ の活動の目的の一つです。超高齢社会を迎えた今、健康問題から目を背ける ことはできません。このプロジェクトが発展し、誰もが元気で天寿を全うで きる、そんな社会が実現するよう願います。また、2025年に予定されてい る深草キャンパスへの移転により、社会学部は大きな転換期を迎えます。他 学部との連携による新たな教育展開で、社会貢献活動がどのように広がっ ていくのか、今から期待しています。
運動強度の高い体操は、うつ病・不安障害の改善効果があり、その改善効果は 実施回数が多いほど高いことが示唆されています。

Ryukoku University 2024 22

Ryukoku University 2024 23
法学部 法律学科

濱中 新吾 教授

中東の政治問題、政策問題、国際情勢などについて、世論調査で収集したデー タをもとにデータサイエンスの手法を使った統計分析を行っています。具 体的には、中東は革命や戦争・紛争、民主主義制度の崩壊といった出来事が 起こる地域ですが、その発生の“謎”をデータで解き明かしています。例え ば、選挙の投票率を上げるために、電話などで投票を呼びかける活動は世界 各地で行われています。ところがイラクでは、電話がかかってくると投票の 意欲を失う人が多いのです。日本やアメリカなどでは投票率が上がるのに、 イラクではなぜ下がるのか?その理由をさまざまな調査や分析、実験をと おして解明していきます。こうした“謎”はその国や地域が抱える政治課題 と結びついていることが多く、謎の解明が問題解決につながります。世界の 動きを知る手がかりにもなり、国際情勢についての理解が日本社会の対応 や政策の判断にも有効です。さらに、今後のデータサイエンスの広がりは、 私たちの知見を広げ、将来的にはいくつかの前提条件のもとに各国政府の 判断や行動が予測可能になると期待しています。
イスラエルと日本の政治に関する研究ワークショップの様子
[研究テーマ]
中東政治論・計量比較政治分析
Ryukoku University 2024 24
中東特有の問題をデータ解析して 国際情勢の正しい理解に役立てる

Ryukoku University 2024 25
龍谷大学の教育
あらゆる「壁」や「違い」を乗り越えるために、「まごころ」を持ち、 「人間・社会・自然」について深く考える人を育む。

それが、龍谷大学の教育のあり方です。
自分自身を省み、人の痛みに感応して、 他者を受け容れ理解する力を持つ。
人類が直面するリアルな課題と真摯に向き合う。
そして様々な学びを通じて本質を見極める目を養い、
自らの可能性を広げていきます。
Ryukoku University 2024 26
More Empathy More Equality

Ryukoku University 2024 27
Faculties
学部・学科・課程・専攻
心理学部
心理学科
ー生涯発達カウンセリングプログラム
ー関係支援とコミュニケーションプログラム
ープログラム横断科目(データ心理学)
学びのキーワード
● 心と行動の関係
● コミュニケーション・スキル
● データサイエンス
● 生涯発達
● 対人支援
● カウンセリング
● マインドフルネス
● コーチング
文学部
真宗学科
経済学部
Faculty of Economics
現代経済学科
ー経済理論プログラム
ー産業経済プログラム
ー応用政策プログラム
経済データサイエンスプログラム
ー学部共通コース
経営学部
Faculty of Business Administration
法学部
Faculty of Law
経営学科
ー経営コース
ー会計コース
ー学部共通コース
政策学部
Faculty of Policy Science
法律学科
ー司法コース
ー現代国家と法コース
ー市民生活と法コース
ー犯罪・刑罰と法コース
ー国際政治と法コース
ー学部共通コース
国際経済学科
ー国際経済プログラム
ー開発経済プログラム
ー経済史プログラム
ー学部共通コース
● 文化財
● 古文書
● 出版・日本語
● 哲学・思想
● 宗教学
● 学校教育
● 英語コミュニケーション
● マーケットデザイン
● 国の借金
● SDGs
● データサイエンス
● 行動経済学
● フィンテック
● 少子高齢化
● 格差社会
● マネジメント
● 企業のグローバル化
● コーポレート・ファイナンス
● アカウンティング
● 経営戦略
● マーケティング
● リーダーシップ
● CSR
page 38
page 44
page 46
● 人権
● 憲法改正論議
● 法曹・パラリーガル
● セクハラ・パワハラ
● 消費者問題
● 少年犯罪
● 国際政治
● 環境問題
page 48
政策学科
ー政策構想コース
ー環境創造コース
ー地域公共人材コース
ー学部共通コース
● 地域的課題
● 環境
● まちづくり
● 地方自治・行政
● 持続可能性
● フィールドワーク
● 市民性
● NPO/NGO
page 50
深草キャンパス
深草/大宮キャンパス (京都市)
(京都市)
仏教学科 哲学科 ー哲学専攻 ー教育学専攻 歴史学科 ー日本史学専攻 ー東洋史学専攻 ー仏教史学専攻 ー文化遺産学専攻 日本語日本文学科 英語英米文学科
Faculty of Letters page
36
Faculty of Psychology
Ryukoku University 2024 28
教養教育
本学の教養教育は、建学の精神に基づく高い倫理性や豊かな人間性とともに 知性・感性を兼ねそなえ、現代社会でたくましく生きる力をもった
人間の形成を目的として開講しています。
「仏教の思想」
伝統を知り、自己を振り返り、幅広いものの見方と心の豊かさを育てる
浄土真宗の精神を建学の精神にもつ龍谷大学は、深い学識と教養をもちながら、国際社会の一員として努力する人間を育成することを めざしています。「仏教の思想」は、本学の建学の精神を学ぶための必修科目として位置づけられ、本学の良き伝統を知り、仏教の思想 を学ぶことを通じて自己を振り返り、幅広いものの見方と心の豊かさを育てることを目的としています。
独自のカリキュラムでつかえる外国語を学び、真のコミュニケーション力を身につける
国際社会における“真のコミュニケーション”は、文化的背景や芸術、生活様式、ものの考え方などを理解したうえで成り立ちます。相手 を理解し、確固とした判断・主張・行動をする素地として、「聴く・話す・読む・書く」という外国語の運用能力のレベルアップを図ります。
※ 国際学部は、学部独自の外国語科目を開講するため、教養教育科目の言語科目は、履修できません。 >>>詳細は P. 31
4つの系列に分類されている教養科目は、各系列から偏りなく履修することを通じ、幅広い知識の修得を可能にしています。
人文科学系科目
哲学入門/倫理学入門/倫理学/クリティカル・シンキング/宗教の世界/日本の文学/アジアの文学/西洋の 文学/日本の歴史/日本の文化/アジアの文化/アジアの歴史/西洋の歴史/心理学/教育原論/学習・発達論 [ 深草のみ ]哲学/宗教学入門/中国の思想/芸術の世界/文章表現法/言語と文化/現代世界の歴史/心 の科学/教育学のすすめ/現代社会と教育/大学論 など [ 瀬田のみ ]宗教学のすすめ/言語学入門/歴史入門/心理学入門 など
里山学/植物の自然誌
教養科目
自然科学系科目
[ 深草のみ ]数学入門/数学への旅/確率・統計入門/宇宙の科学/物理科学の世界/時間と空間の科学/ 自然科学史/地球科学のすすめ/生物科学のすすめ/生命科学のすすめ/生態学のすすめ/人 類学のすすめ/環境学/情報科学入門 など [ 瀬田のみ ]生活の中の数学/生活の中の統計技術/生活の中の化学/生活の中の物理/生活の中の生物学/ 生活の中の地学/生命と科学/現代の技術/自然観察法/環境の科学/人類の科学/情報と人 間/現代社会と栄養 など
社会科学系科目
スポーツ科学系科目
Topic
法学のすすめ/日本国憲法/政治学のすすめ/社会統計学のすすめ/社会学のすすめ/地理学のすすめ/経 済学のすすめ/社会調査のすすめ/経営学のすすめ/国際学のすすめ/文化人類学のすすめ/人権論/現代 社会とメディア/現代社会と福祉/環境と社会/現代社会と法/平和学/ジェンダー論/国際社会論/現代 社会の諸問題/地域論/企業と会計/現代社会と労働/社会思想史/データサイエンス・AI入門 など
健康とスポーツ/現代社会とスポーツ/スポーツ技術学(演習)
[ 深草のみ ]人間とスポーツ/スポーツと人権・平和/スポーツ文化史/スポーツ科学最前線 [ 瀬田のみ ]スポーツ文化論
「データサイエンス・AIリテラシープログラム」を全学的に展開
日本政府は、サイバー空間(仮想空間)とフィジカル空間(物理空間)が高度に統合された社会「Society 5.0」を提唱しています。
このような社会では、フィジカル空間の膨大なデータをサイバー空間に蓄積し、そのデータをAI(人工知能)で解析し、その 結果をフィジカル空間にフィードバックすることで、経済発展や社会課題の解決が実現すると考えられています。このような 新しい社会の到来に備えて、ビッグデータから有用な情報を可視化し、意思決定を行い、機械学習などのAI技術で結果を分析・ 予測するスキルを身につけることが重要です。そのためこれから社会に出る大学生には、データサイエンス・AIに関する基礎 的な知識やスキルが不可欠です。また、社会の変化に対する意識をもつことや、データを扱ううえでの倫理観が求められます。 本学ではこれらのことを学ぶために「データサイエンス・AIリテラシープログラム」を全学的に展開しています。 ※ 同プログラムは短期大学部を除くすべての学部で受講が可能です。
プログラム対象科目(一部抜粋)
● データサイエンス・AI入門
● 社会統計学のすすめ
● 確率・統計入門
● 生活の中の統計技術
科目
人文・社会・自然・スポーツ科学を学び、幅広い教養を身につける
文 心 経 営 法 政 国 先 社 農 [ 深草 ] [ 瀬田 ] 心 先 社 農 文 経 営 法 政 国
[ 必修外国語 ] [ 選択必修外国語 ] [ 選択外国語 ]
言語科目
心 心理学部 文 文学部 経 経済学部 営 経営学部 法 法学部 政 政策学部 国 国際学部 先 先端理工学部 社 社会学部 農 農学部
Ryukoku University 2024 30
外国語教育
1
英語以外の外国語を学修するメリット
複数の外国語を知ることは、言語の構造や機能を理解できるうえ、英語圏以外の さまざまな国や地域の文化・社会を知るためにも役立ちます。
3
情報機器、視聴覚教材などを 効果的に活用した授業を導入
外国語教育にコンピュータや視聴覚教材を効果的につかった授業を導入し、リス
ニングの基礎能力を強化すると同時に、学生の自学自習を促進します。
世界諸地域に広がるネットワークを 活かした国際交流プログラムを開設 5
世界諸地域の大学・研究機関に広がるネットワークを活かし、交換留学や短期語 学研修など、多様な国際交流プログラムを設けています。
◎・・・必修外国語:必ず履修。
●・・・選択必修外国語:1つの言語を選び、必ず履修。
★・・・必修外国語:英語を含む1つもしくは2つの言語を選び、必ず履修。
○・・・選択外国語:自由に選択。
■・・・[ 深草]留学生は原則日本語のみを履修。
2
ネイティブ・スピーカー教員による “生きた外国語”の授業を実施
アメリカやイギリス、中国、ドイツ、フランス、スペイン、韓国など、さまざまな国・ 地域出身の教員が多数、授業を開講しています。
4
学生の英語力に応じたクラス編成で レベル別学修を実施
入学前にプレイスメントテストを実施します。それぞれの学生の英語力に応じた クラス編成を行い、教育効果を高めます。※ 短期大学部は除く
>>>詳細は P.72 ドイツ語 フランス語 スペイン語中国語ポルトガル語コリア語 ロシア語トルコ語アラビア語ペルシア語ギリシア語 ラテン語 日本語
学部別外国語科目
☆・・・短期大学部の留学生は、必修外国語として英語の代わりに日本語を履修することができる。
国際学部の外国語科目は学部の専攻科目として開講しています。
短期大学部の「ドイツ語」「フランス語」は、社会福祉学科の専攻科目として開講しています。
英語と初修外国語(ドイツ語・フランス語・中国語・スペイン語・コリ ア語から1つの言語を選択)を履修します。
学びたい外国語に 重点を置いた教育システム
学びたい外国語を入学時に選び、重点を置いた学修で「聴く・ 話す・読む・書く」といった外国語の運用能力のレベルアップ を図ります。
※ いずれか1つの 言語を選択
国際文化学科: 必修外国語は、入学時に1ヶ国語( 英語のみ週5回 の1言語集中型)、あるいは2ヶ国語(フランス語、 中国語、コリア語のいずれかを週3回と英語を週2 回の2言語型)を選択します。
※ 留学生の必修外国語は日本語になります。
グローバルスタ ディーズ学科:
履修する外国語は英語のみとなります。1年次は少な くとも週6回英語クラスを受講します。
英語2単位必修。
社会福祉学科は「ドイツ語」「フランス語」を選択受講することも できます。
先端理工学部:英語6単位必修
社 会 学 部 :英語 6単位必修、ドイツ語・フランス語・中国語・コリ ア語から1言語2単位必修
農 学 部:英語 6単位必修 必修科目の外国語のほかに、TOEIC®、時事英語、コミュニケーション、文 学、映画、音楽など、より専門的な英語を学ぶことができるように「英語 セミナー」を開講。また、ドイツ語やフランス語、コリア語、中国語に関 しても、「初修外国語セミナー」を開設し、より深く学ぶことができます。
( 留学生のみ) ◎ ◎ ◎ ◎ ◎ ◎ ○○○○○○○■ ★○★★○★○○○○○■ ◎ ◎ ○○ ☆ ◎ ☆ ◎ ○○○○ ○ ◎ ●●●● ● ◎ ○○○○ ○ 文学部 心理学部 経営学部 政策学部 社会学部 短期大学部 こども教育学科 経済学部 法学部 国際学部 グローバル スタディーズ学科 国際学部 国際文化学科 農学部 先端理工学部 短期大学部 社会福祉学科
深草キャンパス 瀬田キャンパス
Ryukoku University 2024 31
Omiya Campus

大宮キャンパス
心理学部(3・4年生)
文学部(3・4年生)
Ryukoku
2024 32
University

Ryukoku University 2024 33
人文科学系の資料を中心に所蔵する大宮図書館。真宗・仏教・史 学・文学のコレクションは質・量ともに日本有数を誇ります。『万 葉集』の歌を春夏秋冬・天地・山水などの題材によって再編集し た平安末期写本『類聚古集』(国宝)、西洋解剖書の日本初の訳本 とされる『解体新書』(初版本)、仏教伝播の道を辿った大谷探検 隊がもち帰った歴史的資料などを多数揃える、貴重書の宝庫です。

Feature 大宮図書館 蔵書数 771,604 冊
Ryukoku University 2024 34
1. 本館 2. 龍谷ミュージアム
大宮キャンパスのシンボル (1879年竣工、国の重要文化 財)。1997年、古きよき佇まい を保ちつつ大改修しました。学 芸員をめざす学生の展示会な ども開催されます。

街に開かれた仏教総合博物館。 図書館や古典籍・文化財デジタ ルアーカイブ研究センターと 連携して学術資料を保存・活用 するとともに、展示事業で仏教 文化の普及にも努めています。


3. スチューデントコモンズ 学修活動のサポートエリア(東 黌1階・2階)。多目的エリア や個人・グループ学習室、プリ ントスポットなどを備え、メ ディア機器の貸出やライティ ング支援も行っています。


4. 南 なん 黌
白亜の壁とアーチ型に連なる 窓が印象的な南黌は、北黌と 対をなす建築物です(本館と 同じく1879年竣工、国の重要 文化財)。夜にはライトアップ され、幻想的に輝きます。
5. 東 とう 黌 こう
本館と対峙する大宮キャンパ スのメイン教室棟。大教室や ゼミナール用の小教室が中心 で、趣のある回廊式の廊下は、 学生の憩いのスペースとなっ ています。
Omiya Campus 大宮キャンパス
1 3 4 5 2 Ryukoku University 2024 35
こう
Faculty of Psychology 心理学部
心のつながりを探究し、 社会に力を生み出す
Question 社会課題の解決に心理学は どう活かせる?
コロナ禍で孤独に悩む人が急増したように、 社会課題と人間関係は密接な関わりがあり ます。その人と人のつながりを心理学的に 深く理解し、他者と共に行動できるように なることで、現代社会の課題を解決に導く 人へと成長します。

Ryukoku University 2024 36
どんな学びができる? Check 1
心理学科
キャリアビジョンにあわせた
専門的な心理学教育の充実を図る「2つのプログラム」とそれらを横断的に接続 する「プログラム横断科目」を配置します。その下には特徴的な心理実践につな がる「9つの分野」の科目群を設定し、学生自身のキャリアビジョンにあわせて、 関心のある分野の科目を自由に選択し、幅広く学ぶことができます。
心理学教育の3つの柱
「心理学基礎科目」「データサイエンス科目」「キャリア啓発科目」の3つの柱(科 目群)を置き、心理学の基礎を学ぶだけでなく、卒業後のキャリアを意識し、実社 会において心理学がどのように活用されるのかを学びます。
心を科学的にとらえる データサイエンスを学ぶ
「データサイエンス科目」では心の動き や行動をデータとして統計的に処理・ 分析し、心のありようを科学的にとら えることを学びます。心理学の領域に おけるデータサイエンスを学びなが ら、情報を扱う際の情報倫理やマナー 等の基本的な素養も身につけます。

どんな4年間を過ごす? Check 2

心理学の専門的な学びの成果 を活かしたキャリアデザイン 初年次から卒業年次まで途切れるこ となくキャリアに関する科目を配置 し、一般的なキャリア教育にとどま らず、心理学の専門的な学びの成果 を活かした自身のキャリアについて 考える教育を展開します。
公認心理師 受験資格課程を開設 心理職の国家資格である公認心理師の 受験資格を取得するためには、学部で の所定科目を履修し、卒業後、大学院 に進学して所定科目を履修し修了また は2年以上の実務経験が必要です。心 理学部では公認心理師受験に向けたサ ポート体制を整備します。
1セメスター2セメスター3セメスター4セメスター5セメスター6セメスター7セメスター8セメスター 3つの柱を通じて心理学の基礎を学ぶ 専門的な学びを深めるための基盤をつくる 関心にあわせた専門的な学修を進める4年間の学びを卒業研究にまとめる
生涯発達カウンセリングプログラム
データサイエンス科目 プログラム横断科目(データ心理学) 関係支援とコミュニケーションプログラム
キャリア啓発科目 キャリア形成科目 公認心理師受験資格課程科目
[めざす職業・進路]
● 企業(企画・開発職、営業職、販売職など)
● キャリアカウンセラー ● 学校心理士
● 行政(心理専門職)
● 公務員(国家・地方) ● NPO/NGO
● 児童福祉施設(生活指導員/児童指導員)
● ビハーラ活動 ● 教員(高等学校)
● 高等学校教諭一種免許状(公民)
● 公認心理師受験資格課程※
● 認定心理士 ● 本願寺派教師資格( 受験資格 )
※ 公認心理師の受験資格を取得するためには、学部における所定科目を履修し、卒 業後に大学院に進学して所定科目を履修したうえで修了する必要があります。
詳しくは学部パン フレットでご確認 ください。
Website 1 年次 2 年次 3 年次 4 年次
教養教育科目 心理学基礎演習 フレッシャーズゼミ 専門基礎科目 専門発展科目 心理学基礎科目
心理学演習(卒業研究含む)
[取得可能な免許・資格]
専門的かつ実践的な「9つの分野」
基礎から卒業後のキャリアまでつながる
生理心理学 産業心理学 医療心理学 発達心理学 臨床心理学 教育心理学 ビジネス心理学 行動心理学 認知心理学 福祉心理学 人格心理学 学習心理学 スポーツ心理学 社会心理学 チーム医療 チーム学校 ネットワーク 支援 産業・ メンタル ヘルス 成人・ 高齢者の 心と支援 乳幼児と 保護者の 心と支援 子どもの 心と支援 思春期・青年期の 心と支援 プログラム 横断科目 データ心理学 < 学べる心理学の例 > 生涯発達 カウンセリング プログラム 関係支援と コミュニケーション プログラム Ryukoku University 2024 37
Faculty of Letters 文学部
Question 社会のなかでどのように 文学が活きるのか?
文学部は6学科6専攻と幅広い分野を有し ていますが、これらに共通するのは言葉と 思考力が基盤になるということ。この世に 言葉が存在している限り、深く掘り下げた 思考をわかりやすく伝える力は、重要な能 力のひとつでありつづけるでしょう。
自分が変わる、世界が開く 人間を深く理解するための学び

Ryukoku University 2024 38
Check 2
1 年次
どんな学びができる?
宗教学、哲学、歴史学、文学、言語学の 視点から人文学を幅広く学ぶ
文学部は、人文科学系の6学科6専攻から構成されています。入学後は、優れた教 員陣の教育指導のもと、本学が所蔵する貴重な文献・資料なども活用し、幅広い 教養と各学科・専攻の専門分野に関する深い知識を修得していきます。
文化財などに触れ 文化・歴史・言語を学ぶ
本学では、大宮図書館の所蔵品をはじ め、貴重な文化財や歴史資料を多数所 蔵しています。これら「本物」を研究対 象に、学生誰もが“1人の研究者”とし て、文化や歴史、言語などを学修するこ とができます。

文学部では、演習( ゼミ)でのフィー ルドワークも積極的に取り入れてい ます。本物の資料や遺跡を実際に見 て、触れることで、学修のプロセス に必要な作法や知識、あるいは研究 方法や思考力を養います。
どんな4年間を過ごす?
2 年次
4年間を通じた演習(ゼミ)で 学修に必要な力を養う 少人数の学生と教員による演習(ゼミ)を 4年間必修科目として配置しています。自 ら見いだした課題に主体的に取り組み、 全員が発表・議論することを通じて、広い 視野と専門的な知見に基づいて研究をす すめるために必要な力を身につけます。
卒業論文の作成で問題を 解決する力を修得する 文学部では、演習(ゼミ)などで身につ けた力を駆使し、全員が卒業論文を作 成します。卒業論文は4年間の学修の 集大成。これまでの学修で得た“問題を 解決する力”を表現物にまで高めて完 成させます。
3 年次
4 年次
1セメスター2セメスター3セメスター4セメスター5セメスター6セメスター7セメスター8セメスター 基礎的なリテラシーを修得
語学力を活かし、難解な専門用語を理 解しながら文献を読む力、さらに資料 の調査に加えてフィールドワークなど から調べる力を養います。
専門的な学修へ
文献やフィールドワーク、留学などで 得た情報・知識を客観的かつ批判的に 読解・分析しながら、創造性のある思 考ができるよう、学びをすすめます。
発表のための力を磨く 卒業論文の作成に向け、説得力ある書 き方、その内容のポイントを効果的に 伝えるためのプレゼンテーションのス キルを磨いていきます。
必修科目
卒業論文をまとめあげる 自分の研究成果をプレゼンテーション し、その内容について教員やゼミ仲間 と共に積極的な議論を重ねることで、 研究の質を高めていきます。
演習I 演習II / 卒業論文 基礎演習
[めざす職業・進路]
● 企業( 営業職、販売職、建築設計、出版・マスコミ、観光、地域再生関連 )
● 教育産業 ● 航空・ホテル・旅行
● 公務員( 国家・地方 ) ● NPO/NGO ● 都市計画
● 学芸員・司書・研究職 ● ジャーナリスト
● 教員( 中学校、高等学校 ) ● 通訳・翻訳 ● 行政
● 観光産業
[取得可能な免許・資格]
● 中学校教諭一種免許状( 宗教、社会、国語、英語 )
● 高等学校教諭一種免許状( 宗教、地理歴史、公民、国語、英語 )
● 図書館司書 ● 学校図書館司書教諭

● 学芸員 ● 社会福祉主事任用資格

● 本願寺派教師資格( 受験資格 )
※ 学科・専攻により取得可能な免許・資格が異なります。 詳しくはP.84,85
詳しくは学部パン フレットでご確認 ください。
Website
バラエティに富んだ 6学科6専攻の学び 哲学科 哲学専攻 歴史学科 仏教史学専攻 真宗学科 歴史学科 日本史学専攻 日本語日本文学科 英語英米文学科 仏教学科 歴史学科 文化遺産学専攻 哲学科 教育学専攻 歴史学科 東洋史学専攻
Check 1
Ryukoku University 2024 39
Fukakusa Campus

深草キャンパス
心理学部(1・2年生)
文学部(1・2年生)
経済学部
経営学部
法学部
政策学部
国際学部
短期大学部
※2025年4月に社会学部が深草キャンパスへ移転します。
Ryukoku
2024 40
University

Ryukoku University 2024 41
蔵書数
1,074,637冊
Feature 深草図書館 社会科学系および人文科学系資料を中心に所蔵する深草図書 館。蔵書数はもちろん、貴重な文庫・コレクションも数多く、 社史・団体史・産業史の資料を約2万点近く収める「長尾文庫」 は日本有数のコレクションです。1,200席超の閲覧スペース をはじめ、個人学習ブースやグループワークルーム、食事がで きるテラス席も配備。学生の充実した学びをサポートします。

Ryukoku University 2024 42
1. 中央広場 2・3. 成就館 キャンパスの中央広場。円状 の屋根と回廊に囲われ、椅子 やテーブルが配置されていま す。大型LEDモニターが備え られたステージは、イベント 時に舞台として活用されます。
課外活動の拠点としての施設。
地域連携やボランティア活動な どの取り組みを学内外に発信す るほか、「Café Ryukoku &」は、 さまざまな出会いを創出する 場として活用されています。






4. 22号館食堂 学生の食を支えるメイン食堂。 20種以上の小鉢から選べる和 食の朝メニューや、注文後に 調理する「オーダーコーナー」 を設置。フレッシュな野菜や 総菜も充実しています。
5. 和 わ 顔 げん 館 かん
ガラス壁が開放的な学修棟。 同時通訳ブース付き大教室や、 可動机・椅子を配した演習室、 職員と学生が交流できる研究 ラウンジなど、多様な学びを 促す設備が揃っています。
6. ナレッジコモンズ 図書館の学術情報を活用して 学び合える“知の交流”空間。 図書館地下1階のオープンス ペースをはじめ、AV&PCコー ナー、グループワークルーム などで構成されています。
Fukakusa Campus 深草キャンパス
1 2 6 3 4 5 Ryukoku University 2024 43
Faculty of Economics 経済学部
Question
経済を学んではじめて 見えてくるものとは?
データやグラフは単なる数値ではなく、私 たちの社会を反映しています。これらを分 析するうちに、物事間の相互関係を発見す る力が身につきます。モノ・サービスの開発 から環境問題の解決まで、あらゆる可能性 を秘めているのが経済学なのです。
文理双方の視点で、一人ひとりの 振る舞いから世界の動向までを 見通し、問題の解決を図る

Ryukoku University 2024 44
Check 1
どんな学びができる?
現代経済学科
経済動向の把握と客観的な分析力で 問題解決を提案
現代経済学科では、「経済理論」「産業経済」「応用政策」「経済データサイエンス」
の4つのプログラムを中心に、ゼミナール、キャリア形成科目を学修。これらの 学びで、最近の経済動向の説明や客観的なデータ分析と計画、立案、提言の能力 の修得とともに、豊かな発想をもち、人や環境への「やさしさ」、快適な生活への 提言ができる人材を育成します。
国際経済学科
国際経済学科では、「国際経済」「開発経済」「経済史」の3つのプログラムを中心に、 ゼミナール、キャリア形成科目を学修。これらの学びで、世界経済のリアルタイ ムな動きが説明でき、コミュニケーション能力を駆使して世界のさまざまな人々 と協力しながら、迅速に問題解決ができる人材を育成します。
「学びの基礎力」「多様なアプローチ」「さまざまな実践の場」を重視した学びで、実践的な力が身につく 経済学部では、初年次から、経済学の基礎科目や基礎力育成科目、キャリア形成科目など、基礎をじっくりと学び、 自身の興味・関心に応じた多様な学修や、さまざまな実践の場による学びをとおして、専門力・実践力を身につけていきます。

データサイエンスを 基礎から学ぶ
ビッグデータ時代の到来によって、データ を収集し分析することで、社会やビジネス の課題を解決していける人材が、あらゆる 仕事で求められるようになってきていま す。経済学部では、このような人材の育成 に、本格的に取り組みます。
Check 2
どんな4年間を過ごす?
先輩学生による
学修支援制度 入門演習・基礎演習Ⅰでは、共通テキス トを用い、先輩学生である授業内ピア• サポーターが学修を支援します。
1 年次 2 年次 3 年次 4 年次
1セメスター2セメスター3セメスター4セメスター5セメスター6セメスター7セメスター8セメスター 幅広い基礎力を身につける 自分の学びを深める学科を選択する 専門力をじっくり鍛える 卒業論文にまとめあげる

・経済学の基礎I
・経済学の基礎II
・会計・法律プログラム ・データを読む能力の育成
・コミュニケーション能力の育成
・キャリア啓発 ・産業・業界研究
・インターンシップ
・仏教の思想、外国語、教養科目など
[めざす職業・進路]
● 企業( 企画・営業職・販売職・海外駐在員など )
● 航空・ホテル・旅行業 ● 研究職 ● 司書
● 教員( 中学校、高等学校 ) ● 通訳・翻訳
● 公務員( 国際・国家・地方 ) ● NPO/NGO

・経済理論プログラム ・産業経済プログラム
・応用政策プログラム ・経済データサイエンスプログラム
・学部共通コース ※国際経済学科の科目も履修可能
・国際経済プログラム ・開発経済プログラム
・経済史プログラム
・学部共通コース ※現代経済学科の科目も履修可能
● 中学校教諭一種免許状( 社会 )
● 高等学校教諭一種免許状( 公民、地理歴史 )
● 図書館司書
● 学校図書館司書教諭
● 本願寺派教師資格( 受験資格 )
※ 学科により取得可能な免許・資格が異なります。 詳しくはP.84,85
詳しくは学部パン フレットでご確認 ください。
世界の人々と協力しながら 迅速に問題解決を図る
[取得可能な免許・資格]
Website
入門演習 基礎演習II 卒業研究 基礎演習I 演習I 演習II 現代経済学科科目 国際経済学科科目 学科選択 基礎力育成科目 教養教育科目 経済学の基礎科目
キャリア形成科目
Ryukoku University 2024 45
Faculty of Business Administration
Question 経営学が役立つのは 企業を経営するときだけ?
問題点を分析し、解決のために手段を講じ る。これは経営に必要な能力であると同時 に、さまざまな課題を解決する力でもあり ます。少子高齢化や過疎化などの社会問題 解決、スポーツマネジメントなど、経営学の 知識は分野を超えて活用されています。

経営学部 めざすは即戦力となる経営人 リアルな現場を体験し、 ビジネスセンスを養う
Ryukoku University 2024 46
どんな学びができる? Check 1
経営学科
現場で学び、現代社会を生き抜く知恵を培う
経営学の主な研究対象は「企業」です。多彩な経営の現場に触れながらその組 織のあり方にアプローチし、製品やサービスの生産、販売プロセスに対して どのように有効性や効率性を向上させることができるかなど、その仕組みを 探究していきます。
経営コース 会計コース
専門分野を深めながら
集合学修で互いの能力を高め合う
経営学部ではビジネスの現場で学ぶ実習教育を重視しています。専門的・実践的 に学ぶことで課題発見能力、課題解決能力を養います。また、仲間と切磋琢磨す ることでビジネスセンスが磨かれ、就職後にも活かせる力が身につきます。


プロジェクトやコンペなど に取り組み、実践力を養う
実社会から学ぶことを念頭に、多彩 な経営の現場に触れ「生きた経営」を 学修。 基礎教育や理論教育での学び をもとに、現場で今後の課題を発見 することで、実践的な経営学を理解 します。
ゼミ活動を通じて、 互いを高め合う ゼミではそれぞれの学生が興味をもっ たあらゆるテーマに関する書籍を読み、 それをまとめて他のゼミ生の前で発表 し、討議します。こうしたプロセスをと おして、論理的に考える力やプレゼン テーション能力を養っていきます。
Check 2
1 年次
学部内外から興味にあわせて 選べる、3つのコース
2年生後期から自分の進路にあわせ てコースを選びます。学部内の「経 営コース」「会計コース」、経済・経営・ 法・政策の4学部が対象の「学部共通 コース」をあわせた計3コースから 選択します。
2 年次 3 年次 4 年次
1セメスター2セメスター3セメスター4セメスター5セメスター6セメスター7セメスター8セメスター 基礎をしっかり身につける
基礎科目
自分にぴったりのコースを選択する社会を見る目をじっくり鍛えるこれまでの経験を卒業論文にまとめる
経営学・会計学の基礎科目を学び、自分が興味をもてる分野を見つけます。
基礎演習 経営学・会計学などをより専門的に学修。
演習 ゼミを選択し、2年間をかけてグループワークやプレゼンテーション、合宿などで学びます。
応用演習
フレッシャーズゼミ
自分の進路にあわせて コースを選択(2年生後期~)
[めざす職業・進路]
● 企業(商社、金融、情報、航空・旅行、介護・福祉など)

● 起業家 ● 公認会計士 ● 税理士 ● ファイナンシャル・プランナー
● 公務員(国際・国家・地方) ● NPO/NGO
● 教員(中学校、高等学校) ● 司書教諭
[取得可能な免許・資格]
● 中学校教諭一種免許状(社会)
● 高等学校教諭一種免許状(地理歴史、公民、商業)
● 図書館司書 ● 学校図書館司書教諭
● 本願寺派教師資格( 受験資格 )
詳しくは学部パン フレットでご確認 ください。
どんな4年間を過ごす?
・経営コース ・会計コース ・学部共通コース
Website
Ryukoku University 2024 47
Faculty of Law 法学部
Question
法学部に所属しているのは 法曹をめざす学生ばかり?
法学部生の進路というと、まず司法関係の 仕事がイメージされがちですが、法学・政治 学の授業をとおして養われる能力は、公務 員はもちろん金融業や不動産業、サービス
業や卸売・小売業など、多様な業種で幅広く 求められます。幅広い分野と関連する法律
学や政治学の知識は、社会に出てからも多 くの場面で役立ちます。
立場の異なる人を どのように説得するか? 法学で、難問を解く

Ryukoku University 2024 48
Check 1
どんな学びができる?
法律学科
確かな法律知識をもち 社会の諸問題を解決する
法学と政治学の教育・研究をとおして修得した広い教養と専門的な知識で、鋭い 人権感覚と正義感のもと、問題を発見・解決できる自立した市民を育てます。
司法コース
現代国家と法コース
市民生活と法コース
各自の関心や、めざす進路にあったコースで 法を学び、リーガルマインドを養成する
不況による解雇・倒産、自動車事故、少年犯罪に冤罪、米軍基地問題など、私た ちの身の回りのあらゆることに法律が関係しています。このような現代社会の 諸問題を、鋭い人権感覚をもって批判的・論理的に分析できる「リーガルマイン ド」を備えた学生を育成します。
犯罪・刑罰と法コース
国際政治と法コース
法政アクティブリサーチ
「法政アクティブリサーチ」は、さ まざまな社会問題を取り上げて、そ れぞれのフィールドにおいて社会の 諸機関と交渉し、実践的に学ぶこと で、社会知識と経験の育成を図るア クティブ・ラーニング科目です。
各コースで段階的に学び、 自らの強みを手に入れる
2年生後期に自分の興味・関心や将来の 希望進路にあわせてコースを選びます。 入学前に抱いていた学生各自の目標、 そして入学後の学びのなかで発見した 新たな目標に応じて「学び」を選ぶこと で、自らの強みを手に入れます。
実践的な学びをとおして、 多彩な分野で 活躍する力を養う

4年間切れ目のない演習による教育 で、法学を基礎から発展まで段階的 に学修。また、フィールドワークに よる調査活動などを行うアクティ ブ・ラーニング科目で実社会で役立 つ実践的な力を養います。
授業や学生生活など幅広く相談 できるクラスサポーター制度 1年次の履修指導科目である「基礎演 習」および「法政入門演習」に、クラス サポーター(2年生以上の上級生)が毎 回参加し、レポートなどの課題への取 り組み方、学生生活に関するアドバイ スなどで、1年生をサポートします。
Check
どんな4年間を過ごす?
1セメスター2セメスター3セメスター4セメスター5セメスター6セメスター7セメスター8セメスター 大学での学び方を修得する 段階的に学修を深めて 関心があるコースを選択する
専門性の高い科目を学び、 リーガルマインドを育てる
法政ブリッジセミナー 演習I 演習Ⅱ・卒業研究
法政アクティブリサーチ
法律事務実務・法律実務論
自分の志望にあわせてコースを選択(2年生後期~)
[めざす職業・進路]
研究テーマを追究し、 卒業研究にまとめあげる
・司法コース ・現代国家と法コース ・市民生活と法コース ・犯罪・刑罰と法コース ・国際政治と法コース ・学部共通コース
● 公務員( 国家・地方 ) ● 裁判所事務官 ● 検察事務官 ● 家裁調査官
● 教員( 中学校、高等学校 ) ● 司法書士 ● 行政書士


● 刑務官 ● 警察官 ● 法務教官 ● 保護観察官
● 法科大学院( 弁護士・検察官・裁判官 )
● 企業( 金融、製造、情報通信、法務関係など )
● 中学校教諭一種免許状( 社会 )
● 高等学校教諭一種免許状( 地理歴史、公民 )
● 本願寺派教師資格( 受験資格 )
詳しくは学部パン フレットでご確認 ください。
[取得可能な免許・資格]
2 1 年次 2 年次 3 年次 4 年次
基礎演習 法政入門演習
合同報告会 専攻基礎科目
専攻科目 クラスサポーター制度
Website
Ryukoku University 2024 49
Faculty of Policy Science 政策学部
Question
少人数の教育に取り組む
政策学部独自の強みとは?
4年間をとおして開講する演習では、学外に 飛び出して活動したり、ときには海外へ向 かうことも。大学での座学でしっかり基礎 や方法論を学び、現場で地域のみなさんと 協働して問題解決に取り組みます。大学と 現場を往復することで、「自分の足りなさ」 を自覚する契機となり大きく成長できます。
枠にとらわれない学びで 未来をデザインする

Ryukoku University 2024 50
どんな学びができる? Check 1
政策学科
持続可能な社会を実現するための「政策」を学ぶ
学際的で実際的な最先端の教育プログラムを用意して、激変する時代のなかで困 難を突破し、未来を切り拓く能力と情熱を育てます。
地域の現場で実践力を養うため 政治、経済、環境などを幅広く学ぶ

政策学部はグローバルな視野をもち、実際に地域に入って地域が抱える具体的な問 題を解決に導く人材の育成をめざします。そのために、環境学や経済学、社会学な ど多様な分野から持続可能な社会を構築するための理論や分析手法を学修します。
持続可能な社会の実現を めざし、地域の課題を 多角的に学ぶ

政策学部は少人数での授業を重視しており、3つのコースに分かれて各分野の学びを深めていま す。また、フィールドワークやインターンシップで地域・企業・NPOなどの現場を体験する機会 を数多く用意しています。
アクティブ・ラーニング科目で
課題発見・解決能力を磨く
「政策実践・探究演習」では、さまざ まなプロジェクトを用意。実際に地 域に出て主体的にフィールドワーク を行うことで、課題を発見する感性 や調査研究の方法、解決策の企画な どの実践的な力を身につけます。
持続可能な社会の実現には、多角的な視 点から柔軟な答えを生み出すことが大 切です。グローバルな視野をもち、地域 が抱える課題を解決できる人材「地域公 共人材」の育成を目標にしています。
学外の団体と連携し、 正課外でも地域の課題に 取り組む

「京都市伏見いきいき市民活動センター」 を拠点とした“Ryu-SEI GAP(Glocal Action Program)”など、正課外でも しっかり地域と向き合い、課題解決に取 り組みます。
Check 2
どんな4年間を過ごす?
1 年次 2 年次 3 年次 4 年次
1セメスター2セメスター3セメスター4セメスター5セメスター6セメスター7セメスター8セメスター
教養教育科目
専攻科目 グローバル・シチズンシップ・エデュケーション科目
専攻導入科目・専攻基本科目
専攻コース科目・コース共通科目
・政策構想コース .........日本、そして世界の地域政策を学ぶ ・環境創造コース .........環境にやさしい社会を実現する政策主体の役割を創造する 地域公共人材コース ...地域社会および地域政策の担い手としての職業人をめざす
・学部共通コース
[めざす職業・進路]
コミュニケーション・ ワークショップ 演習
政策学研究発展演習I~V
政策実践・探究演習(国内)・(海外)
[取得可能な免許・資格]
● 自治体職員 ● 国家公務員 ● NPO/NGO ● シンクタンク
● 民間企業の企画部門 ● 環境問題に取り組む企業
● メディア系企業( 放送・新聞 ) ● 政治家 ● 地方議会議員
● ジャーナリスト ● 金融機関 ● 国連など国際機関の職員
● 社会起業家 ● 大学院進学 など
● 中学校教諭一種免許状( 社会 )
● 高等学校教諭一種免許状( 公民 )
● 本願寺派教師資格( 受験資格 )
●「 地域公共政策士 」資格制度 「 初級地域公共政策士 」
詳しくは学部パン フレットでご確認 ください。
政策構想 コース 地域公共人材 コース 環境創造 コース
企業の CSR実践演習 グローカル 戦略実践演習
演習I 演習II(卒業研究含む) 基礎演習I 基礎演習II キャリア・コミュ ニケーション演習 地域課題発見演習
Website Ryukoku University 2024 51
学部共通コース
学部の枠にとらわれず学際的に学ぶことで 多様な知識と幅広い視野を身につけます
多面的に異文化社会の情勢を 学び、また、意思疎通の道具 となる語学を学ぶことによ り、国際社会の一員として必 要な幅広い視野とコミュニ ケーション能力、そして、豊 かな感性を育みます。

スポーツを中心に、人間の健 康を創出するための手法につ いて、また、自然と人間が共 生していくための今後の社会 づくりについて、社会科学・ 人文科学・自然科学を融合さ せて学びます。

政策学部 法学部 経済学部 経営学部 ▶ ▶ 2 年生後期からコース選択 学部共通コース 学部内コース ▶ ▶ ▶ テーマ別選択 異文化共生 人間環境共生
Ryukoku University 2024 52
学部共通コースの特徴

1. 経済学部・経営学部・法学部・政策学部の4学部が対象。
2. 2年生後期から、コースを選択して学修をすすめることができる。
3. 学部を横断した単位修得が可能。
4. 興味・関心・将来の目標にあわせて学べるバラエティに富んだ講義。
5. 豊富な大学の資源を活かし、幅広く、専門的に学修。
国際関係コース
“The world is our field.”の視点から、 現代国際社会の問題に 多角的にアプローチします。
世界では言語・宗教・習慣の異なる人々が多様な文化 や社会を営んでいます。それらのなかで興味をもっ たことを、必修科目「国際関係論Ⅰ」「地域研究入門」 をもとに、深く学ぶことができます。
異文化交流に必須の 語学運用能力を磨き、世界に向けた コミュニケーション能力を高めます。
英語圏出身の教員などがレベルに応じた少人数クラ スを担当し、英語による授業を行います。生きた英 語を学んで語学力アップをめざし、国際交流に必要 な高度なコミュニケーション能力を養います。
興味に応じて学部を横断した 科目履修が可能
国際関係コース独自の 地域研究ゼミナールを開講
国際関係コース独自の 海外研修制度を設置
スポーツサイエンス コース
スポーツの科学は多角的。 社会科学・人文科学・自然科学を融合させ 次代のスポーツ文化の担い手を育てます。
スポーツへの興味を入り口に、各学部の学びと並行 しながら、スポーツに関する人文・社会・自然科学系 の科目を学びます。多様な資質を身につけた、スポー ツ文化を創造する担い手を育成します。

地球のためにできることを。
環境サイエンス
コース
環境と経済が両立する、持続可能な 社会をつくる方法を考えます。
人文・社会・自然科学の知を統合させ、環境問題の解 決方法を探ります。「未来世代への責任と、自然共生 型の持続可能な社会の構築」を念頭に、新しいライ フスタイルのあり方を築く力を培います。
英語圏出身の教員などが 実践的な英語を指導
基礎から応用まで、 段階別学修で実力をつける
世界各国・地域の文化や歴史の違いを 理解し、柔軟な感性を育む
人文・社会科学系 の視点から「スポーツ」を考察
「スポーツ」を、 指導・マネジメントできる人材育成
実験・実習を含む自然科学系の 学びから「スポーツ」を考察
「エコロジー」と「自然史」を基本に 環境と経済との両立をめざして
野外実習を通じて自然に触れることで 環境について考える
▶ ▶ ▶ ▶
英語 コミュニケーション コース
Ryukoku University 2024 53
Faculty of International Studies 国際学部
Question

「グローバル化」とは? 「国際化」とは?
「グローバル化」とは国境を超えた関係構築 で、「国際化」は言語や文化などを乗り越え て国家間がつながること。国際学部では「グ ローバル化」、「国際化」の違いを理解し、世 界と日本をつなぐリーダーやファシリテー ター(促進者)の素養を身につけます。
世界を舞台に活躍するための 幅広い教養と
コミュニケーション能力を修得する
Ryukoku University 2024 54
どんな学びができる? Check 1
高い語学運用能力をベースに留学などで国際感覚を磨く
グローバルスタディーズ学科では、専門科目の多くが英語または英語+日本語で開講され、高度な英語コミュニケーション能力を養います。
国際文化学科では、英語を中心とした11もの外国語から選んで学修し、国境や文化の違いを超えて考える力を養います。

グローバルスタディーズ学科 世界を舞台に活躍するリーダーを育成
グローバルスタディーズ学科では、1セメスター以上の留学 ※ が必修、 TOEIC®L&R730点などを卒業要件としています。世界情勢を複眼的な視点から学 ぶ専門科目教育をとおして、グローバルな視点からの知識と思考力、文化や習慣 の異なる人々と協働するためのコミュニケーション能力、世界でも通用する倫理 観を身につけます。 ※ 留学先により異なりますが、現地での授業は15週間程度となります。
『世界を学び、私を知る』をキーワードに、世界の多様な言語と文化を学び、〈私〉 を取りまく文化の理解を深め、世界に向けて日本文化を発信できる人材、異なる 文化間に生じる問題を調整することのできる人材、そして国際社会における多様 性の尊重に貢献できる人材を育成します。そのために、学生自身の関心に基づき、 以下の5つの科目群などから専攻科目50単位を卒業要件として履修します。
Check 2
どんな4年間を過ごす?
1 年次 2 年次 3 年次 4 年次
1セメスター2セメスター3セメスター4セメスター5セメスター6セメスター7セメスター8セメスター 外国語・学科科目の基礎を しっかり身につける
専門的な学びに踏み込み、 1セメスター以上の留学※へ
1~2年生で培った英語力を活かす 専門講義科目がスタートする 4年間の学びの集大成 英語による卒業論文作成へ
さらに高度な外国語と、 自分にあった科目群や科目を選択 より興味・関心にあわせた ゼミで学ぶ これまで取り組んできたテーマを 卒論演習でまとめあげる 国際文化学科
大学での学びに向け、語学と その他の学びの基礎を身につける
[めざす職業・進路]
学科専攻科目 「比較宗教」「地域研究」「人間と共生」「メディアと社会」「芸術・表現」の5つの科目群から系統的に履修し、専門を深める 海外研修(北米、ヨーロッパ、東アジア、東南アジア、オセアニアなど)
国際ツーリズムプログラム(ITP) 「観光客」「観光業」「観光地」など、国際的な観点から多面的に学ぶ 短期留学・長期留学(交換留学・私費留学・Ryukoku Intercultural Program)
● 民間企業の国際部門 ● 通訳・翻訳 ● 出版社 ● 国連などの国際機関
● NPO/NGO ● 公務員 ● 企業( 航空業、運輸業、貿易、観光業、商社、IT、石油関係 )
● 英語科教員( 中学校、高等学校 ) ● 学芸員 ● 日本語教員 ● 研究者
● マスメディア( テレビ、新聞、出版、広告 )
● 海外大学院進学
D
※ 留学先により異なりますが、現地での授業は15週間程度となります。
[取得可能な免許・資格]
● 中学校教諭一種免許状( 英語 )
● 高等学校教諭一種免許状( 英語 )
● 学芸員
● 本願寺派教師資格( 受験資格 )
詳しくは学部パン フレットでご確認 ください。
国際文化学科
多様な他者をつなぐ人材を育成
エシックス
コミュニ
領域 比較宗教 芸術・表現 地域研究 メディアと 社会 人間と共生
グローバリ ゼーション領域
領域
ケーション
Website
演習Ⅰ・Ⅱ 学科基礎科目 リサーチ 方法論A リサーチ 方法論B
学科外国語科目
演習 インターンシップ・アブロードⅠ・Ⅱ 演習III 卒業論文 学科外国語科目
留学プログラム 学科専攻科目 プロジェクト
卒論演習B 専門演習B リサーチセミナーⅡ 卒論演習A 専門演習A リサーチセミナーIII リサーチセミナーⅠ
卒業論文 国際文化Study Project A ~
演習IV Ryukoku University 2024 55
Junior College 短期大学部
Question
「2年で卒業」以外の 短期大学部の特色は?
実践的な学びが短期大学部の特色です。社 会福祉学科、こども教育学科ともに複数回 の実習や体験活動があるほか、それに伴う 事前・事後指導も充実しています。龍谷大学 をはじめとした4年制大学への編入学に対 しても手厚くサポートしています。
人を学び、人と学び、人に学び、 人を支える人になる

Ryukoku University 2024 56
社会福祉学科 こども教育学科
Check 1
どんな学びができる?
社会福祉学科
豊富な福祉体験や実習で実践的に学ぶ
社会福祉学科は現場での実習を重視し、実習科目を1つ以上必修としています。 在学中に実習を行い社会経験を積むことで、自身の世界観を広げます。ほかにも、 障がい者と学習支援を通じて協働する「ふれあい大学」や、海外で福祉について 学ぶ「海外研修」などがあります。
充実した実習で「人」と関わり合いながら 福祉や保育・幼児教育の知識と技術を修得する
高齢者施設、障がい者施設、児童福祉施設、保育所、幼稚園など、めざす資格や将 来の仕事にあわせた豊富な実習先を用意。実習後も体験した事例を仲間と共有し つつ振り返る「やりっぱなしにしない」教育が特徴です。
※学科によって選択できる実習先は異なります。
こども教育学科
保育・幼児教育のエキスパートへ
こども教育学科は保育所・児童福祉施設や幼稚園での実習はもちろん、その実習 経験をさまざまな角度から徹底的に見直し、決して「やりっぱなしにしない」こ とが大きな特徴です。座学(理論)と保育実習(実践)の双方を重視した本学なら ではの多彩な授業を用意しています。
学内外での実習をとおし 学び続ける実践者をめざす 学内外での豊富な実習をとおして 「共 ともいき 生 」について学び、考え、実践し ていく力を養うことで、豊かな人間 性・専門知識・実践的能力を身につ けた、現場から学び続ける実践者を 育成します。
社会福祉学科では1年生の8月か ら福祉体験活動が、こども教育学 科では1年生の2月から実習が始 まります。各学科では実習事前指 導、実習事後指導にも力を入れて おり、学生は安心して実習に取り 組むことができます。各実習で、 現場での実践力を養います。
1 年次
ゼミ選択
基礎演習 社会福祉士国家試験受験基礎 資格取得、編入学・就職につい て考える
保育士 養成 課程 教職 課程

(夏期休暇) ゼミごとの 見学実習旅行 福祉体験活動
保育の基礎理論と実践を学ぶ
保育実習指導Ⅰ
保育実習指導Ⅱ
保育実習Ⅰ (保育所) 教育実習 (春期)
福祉・教育に関する資格を 携え、いち早く社会へ 社会福祉士国家試験受験基礎資格、 保育士資格、幼稚園教諭二種免許状、 社会福祉主事任用資格など、学びに 応じて多様な資格をめざし、社会に 出ても学び続ける基礎力を培います。
4年制大学と施設を共有し 総合大学のメリットを享受 情報教室、図書館、ラーニングコモ ンズ、食堂などすべての施設を4年 制大学と共有しています。また、キャ リアセンターでは、学科ごとにガイ ダンスやセミナーを開催し、学生の 就職活動をサポートします。
ゼミ ゼミ 卒業論文提出(11月) 実習事前指導
(夏期休暇) 2年次実習
保育実習Ⅱ・Ⅲ (保育所・施設)
保育実習指導Ⅲ 教育実習
・2年間で保育実習(3回)、教育実習(2回)を実施 ・各実習の事前事後指導、実習報告会による学びの共有
[めざす職業・進路]
[社会福祉学科]
● 社会福祉施設 ● 一般企業 ● 国際NPO/NGO
● 本学4年制学部・他大学への編入学
[こども教育学科]
● 保育所 ● 保育所以外の児童福祉施設 ● 幼稚園
● 認定こども園 ● 本学4年制学部・他大学への編入学


[取得可能な免許・資格]
[社会福祉学科]
● 社会福祉士国家試験受験基礎資格
保育実習Ⅰ (施設)
保育実践力を 身につける
保育・教職実践演習(幼稚園) 学び続ける保育者をめざす
教育実習 (秋期) 実習報告会
● 社会福祉主事任用資格 ● 本願寺派教師資格( 受験資格 )
[こども教育学科]
● 保育士資格 ● 幼稚園教諭二種免許状
● 社会福祉主事任用資格 ● 本願寺派教師資格( 受験資格 )
※時間割の都合によって、複数の教職・資格課程を並行して履修することができない場合があります。
詳しくは学部パン フレットでご確認 ください。
Website
2
どんな2年間を過ごす? Check
2 年次
実習事後指導
ゼミ
Ryukoku University 2024 57
Seta Campus

瀬田キャンパス
先端理工学部
社会学部 ※2025年4月、社会学部は深草キャンパスへ移転します。 農学部 Ryukoku University 2024 58

Ryukoku University 2024 59
蔵書数

Feature 瀬田図書館
先端理工学部・社会学部・農学部という学部構成にあわせて、自然 科学系、社会科学系、人文科学系の資料をバランスよく所蔵してい る瀬田図書館。グループ研究やディスカッションが可能なスペー スであるナレッジコモンズや、42台のパソコンが配置されたイン ターネットコーナー、25席の個人ブースが設置された視聴覚コー ナーなど、さまざまな学びをサポートする環境を整備しています。
493,039 冊 Ryukoku University 2024 60
にせず屋外講義やクラブ・サー クル活動、イベントなどを行 えます。広さは、野球場の内 野部分、テニスコート3面分、 フットサル2面分です。
講義で利用するほか、陸上競 技部、ソフトボール部、ラクロ ス部などが日々活動を行う場 となっています。

展示ギャラリーや会議室、イベ ントホールなど、「学生がやり たいことを自由にできる場所」 をコンセプトに建てられまし た。イベント時には地下1階が 舞台に、階段が客席に早変わり。


学生による主体的な「ものづ くり」と「デザイン」をとおし た学生間の交流、地域コミュ ニティとの連携などを目的と した活動空間として2022年4 月に誕生した複合施設です。

「多様な学びの空間」がコンセ プトの学修支援施設。グロー バルコモンズやスチューデン トコモンズを設置するほか、 生協購買部や旅行カウンター、 丸善書店があります。

Seta Campus 瀬田キャンパス
1. SETA DOME ドーム型の練習場。天候を気
2. 多目的グラウンド
4. STEAMコモンズ
3. 学生交流会館
5. 智光館
1 2 3 4 5 Ryukoku University 2024 61
Faculty of Advanced Science and Technology 先端理工学部
Question
先端理工学部とは?
学生一人ひとりが高い倫理観をもち、自分 自身の先端をめざし、社会に貢献してほし い。「先端理工学部」には、そんな願いが込 められています。AIやデータサイエンス、 航空宇宙などの新たな領域のほか、先が見 通せないこれからの時代において社会課題
の解決に果敢に挑む「フロンティア精神」 を備えた人材を育成します。
研究対象はSNSから宇宙まで 人に寄り添う科学で未来を拓く

Ryukoku University 2024 62
どんな学びができる? Check 1
未来を支える理工学であるために、課程制による新しい教育システム
多様な価値観が共存する社会への転換が求められている現在、国連では持続可能な社会をつくる取り組みをすすめているほか、日本政府はIoTやAIなどの技術で社会的課題 の解決をめざしています。このような課題に対応するべく、先端理工学部では、従来の理工学の枠を超え、先端技術を学ぶ6つの課程制を導入しています。所属する課程で 専門性を担保しながら、異分野を横断的に学修できる環境を整えています。
数理・情報科学課程

物事を論理的に考え適切に表現する力、課題を数 学的・数量的に分析し解決する力、IT社会に柔軟に 対応し活躍できる力を備えた人材を育成します。
機械工学・ロボティクス課程
機械工学・ロボティクスの幅広い知識・技術を修得 し、それを実際に応用できる能力を身につけた人材 を育成します。
25の多彩なプログラムで 横断的な学びを促進
「プログラム」とは、あるテーマに関連 する科目を20単位程度でパッケージ化 したもので、例えば「IoT・通信ネットワー ク」のプログラムには「半導体デバイス 工学」や「知能ロボット」などの科目を パッケージングしています。学生は興味・ 関心があるプログラムを自由に選択で き、分野横断的・主体的に学べます。
カリキュラムにしばられず 主体的に活動できる「R-Gap」
3年次の第2クォーターと夏期休業を合わせた 約3ヶ月間を主体的に活動できる期間「R-Gap (Ryukoku Gap quarter)」と位置づけています。
必修科目がないため、学生は自ら計画を立てて 調査や研究活動などを行えます。他にも海外留 学やインターンシップ、ボランティアなどさま ざまな活動内容が想定されます。
知能情報メディア課程
多様化・高度化するメディア時代にあって、人や 環境にやさしい情報社会の実現に貢献でき、情報 産業の創造・発展に寄与できる人材を育成します。
応用化学課程
自然やモノづくりを理解し、化学的な問題や課 題に対して応用化学の立場から持続可能な社会 を築くことができる人材を育成します。
電子情報通信課程
電子・情報・通信の3分野の基礎から実践的応用までを系 統的に学修し、電子デバイス、情報システム、通信ネット ワークなどの開発を推進し得る人材を育成します。
環境生態工学課程
生態学に立脚した自然への理解と環境工学的な課 題解決アプローチを学修し、環境問題に対して創造 的に課題解決法を提案できる人材を育成します。
数理解析 現象の数理 情報科学 リアル&バーチャルメディア 応用ソフトウェア
電子デバイス・マテリアル IoT・通信ネットワークスマート情報システム先進機械工学 航空宇宙
エネルギー 生命機能化学 高機能新素材 環境共生都市環境テクノロジー
環境インフラ生物多様性サイエンスデータサイエンスモバイルロボティクス先端ロボティクス
バイオニックデザイン先進エコマテリアル 人工知能先端環境モニタリングSDGs(持続可能な開発目標)
どんな4年間を過ごす?
基礎をしっかり
身につけられるように 学びの土台をつくる
所属する課程の専門分野の 基礎知識をしっかり学び 実験・実習の基礎技術を体得
専門科目が本格化 自身の興味関心に応じて 他分野プログラムの履修も可能
R-Gap
25 の多彩なプログラム
4年間の集大成 卒業研究がスタート 進路を明確にして具体的な活動を
[めざす職業・進路]
● 教育業界 ● 情報通信業 ● システムエンジニア(SE)
● 音響・画像・ゲーム関連企業 ● ソフトウェア開発者 ● システムアナリスト
● ITコンサル関連企業 ● 航空機製造業 ● 自動車製造業
● セラミックス・金属等の素材企業 ● エネルギー系・食品系企業
● 化学薬品・化粧品メーカ- ● 公務員 ● 建設土木のコンサルタント
[取得可能な免許・資格]
● 中学校教諭一種免許状(数学、理科)
● 高等学校教諭一種免許状(数学、理科、情報、工業)
● 学芸員 ● 本願寺派教師資格( 受験資格 )
● 技術者・研究者(電気機器、電気通信、半導体、機械、宇宙工学、バイオ、環境保全、環境プラントなど)
● 教員(中学校、高等学校) ● 大学院進学
※ 課程により取得可能な免許・資格が異なります。
詳しくは学部パン フレットでご確認 ください。
Website
詳しくはP.84,85
Check 2 1 年次 2 年次 3 年次 4 年次 前期 後期 前期 後期 前期 後期 前期 後期 1Q2Q3Q4Q1Q2Q3Q4Q1Q2Q3Q4Q1Q2Q3Q4Q 4年間の土台をつくる 基礎の学び 専門基礎を学ぶ 確実な学び 専門力を鍛える 主体的学び 研究に専念 深く広い学び
Ryukoku University 2024 63
Faculty of Sociology 社会学部
Question
社会学部は社会の何を どのように考えているのか?
日常生活で「社会現象となっている」という 表現に出合います。社会現象が指すのは、モ ノ・サービスの流行からいじめや貧困など の社会問題などと多岐にわたります。社会 学部ではこうした社会現象の要因を探り、 社会を個と結びつけて考えます。

徹底した「現場主義」で、 現代社会にアプローチ
Ryukoku University 2024 64
どんな学びができる? Check 1
社会学科 社会の問題を解明する 企画立案能力をもつ人材を育成
フィールドワークを重視し、学生と教員が一体と なって学修・研究活動を展開。身近な人間関係から 地球温暖化問題まで、人間社会が抱える問題を考 え、解き明かします。
コミュニティマネジメント学科 「地域社会を

人が生き生きと暮らせる地域社会をめざし、住む人 の視点に立つ、コミュニティリーダーを育成。地域の 再生と活性化を「人」の力によってすすめていきます。
現代福祉学科 福祉の知見を活用し、 社会貢献ができる人材を育成
複雑化する現代社会の福祉問題を解決するために、「人を支 える思いをかたちにする」現代福祉学の学びを提供。学外に おけるさまざまな実習をとおして、多様な領域で福祉の知 見を活用した支援や社会貢献ができる人材を育成します。
「現場主義」をキーワードに 現実に即した実践的な学びを展開
理論を知ることや文献を読むことも必要ですが、それ以上に社会学部では仮説を立て現地で 検証し、実態を知るというフィールドワークを重視しています。人間の共同体である社会・組 織のあり方を学ぶ社会学は、実際にそのなかへ飛び込んでいかないことには、本当の理解を 得ることはできません。社会学部では、「社会」のあり方を学び、人と人、人と組織・社会との 関わりなど、さまざまな社会問題を解き明かしていきます。また、教室で学んだ理論を現場で 実証し、その結果を理論に反映させる「現場主義」をキーワードに、実習を重視した実践的な 学びを展開しています。

各自の関心や進路に応じて選べる
自由度の高いカリキュラム
社会学部は「自主的な学修」を重視しています。学びの主体はあくまでも学生一 人ひとり。それぞれの学生がやりたいことを見つけ出し、各自の関心や進路に応 じて科目を選択できるカリキュラムを展開しています。
Check 2
1 年次
2 年次
企業・団体と協力し 地域や社会制度の問題解決をめざす
地域社会の活性化について調査し、学生と地域住民がともに考え、課題に取り組 み、問題解決をめざします。また、社会で必要とされる調査・分析力、コミュニケー ション力の育成をめざします。
3 年次
4 年次
1セメスター2セメスター3セメスター4セメスター5セメスター6セメスター7セメスター8セメスター 基礎をしっかり身につける 社会を見る目をじっくり鍛える
初年次学生支援の充実
少人数ゼミ
ゼミや入門科目に、大学院生や上 級生がゼミサポーターとして授業 に参加して、1年生の指導や相談 に対応し、きめ細かいサポートを 行います。
[めざす職業・進路]
基礎をしっかり学んで学外へ
専門科目の学び
専門の基礎科目をとおして「社会」
のあり方を学びます。地域と協働す る学外実習など、現場での学びがス タートします。この時期から留学プ ログラムに参加する学生もいます。
● 公務員(国家・地方) ● NPO/NGO ● 行政機関
● 放送・通信関係、マスコミ・広告関係
● 金融機関、メーカーの商品開発・広報 ● 社会福祉施設・保健医療機関
● 行政機関、都道府県・市町村の社会福祉協議会
● 教員(中学校、高等学校)
● 社会福祉施設(児童福祉施設、障がい者支援施設、高齢者福祉施設など) のソーシャルワーカー
本格的な調査・実習に取り組む これまでの経験を 卒業論文・卒業研究にまとめる
現場経験を実践力につなげる
現場主義 「現場主義」に基づき、各学科がそ れぞれ特徴のある実習プログラム を展開。地域での調査活動や福祉 施設での実習を行います。
[取得可能な免許・資格]
● 中学校教諭一種免許状(社会)
● 高等学校教諭一種免許状(地理歴史、公民)
● 社会教育主事任用資格*
● 社会調査士 ● レクリエーション・インストラクター
● 健康教育専門士 ● 社会福祉士国家試験受験資格
4年間の集大成 ゼミ活動と卒業論文・卒業研究 3年生から始まったゼミに引き続き、 卒業論文・卒業研究に取り組みます。
4年間の集大成として、これまでの 実習や学修経験をまとめます。
● 精神保健福祉士国家試験受験資格 ● 本願寺派教師資格( 受験資格 )
● 社会福祉主事任用資格 ● 児童指導員任用資格
* 卒業後1年以上の実務経験が必要 ※ 学科により取得可能な免許・資格が異なります。 詳しくはP.84,85
どんな4年間を過ごす?
元気にする人材」を育成
詳しくは学部パン フレットでご確認 ください。
Website Ryukoku University 2024 65
Faculty of Agriculture 農学部

Question
農学部で学ぶ4年間は 毎日農業づくし?
農学部では「食」と「農」に幅広い視野で取 り組んでいます。農作物を育てるための理 論や技術、栄養や健康、衛生などの自然科学 分野はもちろん、生産や流通、地域経済から 世界経済などの社会科学分野からも「食」と 「農」を学んでいます。
「食の循環」から農をとらえ、 地球的課題の解決を図る
Ryukoku University 2024 66
生物学基礎
基礎生物化学
Check 1
どんな学びができる?
生命科学科 生命のしくみを学ぶ
最先端の生命科学の知識と技術を学び、多彩な生命現象を題材とした研究に取り 組むことで、「食」を支える「生命のしくみ」を分子レベルで理解し、幅広く応用 できる人材を育成します。
食品栄養学科
栄養と健康のしくみを学ぶ
栄養や健康の観点から農作物をとらえ、人が健やかに生きるための「食」について学 び、食べ物の生産から流通までを理解した管理栄養士を育成します。
農学科
農作物生産のしくみを学ぶ
土壌・作物・収穫物などの管理技術や高度な分析技術など、環境に配慮した作物 栽培の理論と技術を学び、食や農に関わる現場において高い問題解決能力をも つ人材を育成します。
食料農業システム学科
地域社会と経済のしくみを学ぶ
「食」や「農」を支える生産・流通の社会的なしくみを学び、食や農の問題を「社会や 経済のしくみの問題」としてとらえ、その解決の糸口を探ります。
文系・理系の枠組みを超え、現場に即して実践的に学ぶ
生産から加工・流通・消費など、多角的な視点でとらえ、農作物を育てる技術、最新の科学技術を駆使した新しい「知」の発見、「食」や「農」の社会問題、 栄養と健康などを、文系・理系の枠組みを超えて実践的に学び、現場感覚や社会人基礎力をもった人材を育成します。
4学科共通の実習を とおして、食の循環を知る
農作物の栽培・収穫・加工・流通に至 る一連の流れを「食の循環」とし、そ れぞれのプロセスを1年生後期と2年 生前期で実際に体験します。学科を 超えて現場で学び、感じたことを、各 分野での活動に活かします。
農学を学んだ人材を、 社会は求めている 「食」や「農」に関連する産業は、日本や世 界の重要産業であり、技術だけでなく社 会や経済の問題でもあります。自然科学 と社会科学の枠組みを超えた総合的な農 学教育を受けた人材は、社会の多彩な領 域で活躍することが期待されています。
どんな4年間を過ごす?
「農」を理解した 管理栄養士の教育 食品栄養学科では、指定された科目 を修得することで、管理栄養士国家 試験受験資格を得ることができます。 受験特別対策講座や、個別指導など のサポート体制により、2022年度に は合格率98.6%を達成しました。
食料農業システム学科に おける学修プログラム SDGsと食料・農業・環境に関する科目 (食料農業システムSDGsプログラム) や、地域農業マネジメントに関する科目 (地域農業マネジメントプログラム)を 履修することで、その分野を深く学びま す。また、修了要件を満たすと、修了証 を受け取ることができます。
1セメスター2セメスター3セメスター4セメスター5セメスター6セメスター7セメスター8セメスター 基礎知識、能力を自分のものに研究活動に向けたベースづくり実験・実習で専門を高める特別研究および進路準備に注力
入門ゼミ
食の循環実習
農学概論 農学部インターンシップ 特別研究
[めざす職業・進路]
● 農業関連企業・農業関連団体
学科応用分野・実習科目など
[取得可能な免許・資格]
● 管理栄養士国家試験受験資格 ● 栄養士
● 管理栄養士(公務員・病院・学校・保健所・福祉施設など)
● 化学・医薬品メーカー ● 食品・飲料メーカー ● スーパー・流通 ● 商社
● 金融機関 ● 公務員 ● 技術職 ● 教員(中学校・高等学校理科、高等学校農業)
● 栄養教諭 ● 大学院進学 など
● 食品衛生管理者任用資格 ● 食品衛生監視員任用資格
● 中学校教諭一種免許状( 理科 )
● 高等学校教諭一種免許状( 理科、農業 ) ● 栄養教諭一種免許状
● 本願寺派教師資格( 受験資格 ) ● 学芸員
※資格取得をめざす学生を対象に、土壌医検定や農業技術検定、TOEIC® L&R IPテストの受験料をサポートします。

※ 学科により取得可能な免許・資格が異なります。 詳しくはP.84,85
詳しくは学部パン フレットでご確認 ください。
Ryukoku University 2024 67
2 1 年次 2 年次 3 年次 4 年次
Check
学科基礎科目A・B
基礎演習 総合演習
食と農の倫理 海外農業体験実習 数学基礎 フォローアップ教育
Website
※学科によって演習科目の名称や開講期が異なります。
※農学科では、指定科目を修得し、卒業後、日本緑化センターの認定を受けることで、樹木医補の資格を取得することができます。
龍谷大学の国際交流
留学生と気軽に交流できる場をつくり 多文化共生キャンパスの実現をすすめています。 異文化や多様性を受け入れて 海外での活躍にとどまらず、グローバルな視野を ローカル(地域)でも発揮できる人材を育てます。

Ryukoku University 2024 68
Less Borders More Bridges

Ryukoku University 2024 69
To the World
龍谷大学から世界へ
世界 34 ヶ国・地域へ 530人が留学
交換留学では、世界各地の学生交換協定校から留学先を選択できます。また、本学の海 外拠点で展開されるRIP(Ryukoku Intercultural Program)※や、自分で行き先と期間を
決定し大学の許可を得て留学する私費留学、教養教育科目である海外英語研修、短期海 外派遣プログラムなど、海外で学ぶ機会を豊富に用意しています。
※2021年度までBIE Program
From the World
世界から龍谷大学へ
38 ヶ国・地域から、
672 人が 龍谷大学へ
本学では、世界の多様な国や地域の留学生が学んでいます。また、留学生と本学学生 が気軽に交流できる場を積極的に用意しています。今後も、日本文化や伝統、歴史的 建造物の宝庫である京都を舞台に、多文化共生キャンパスの実現をめざします。
アメリカ 175名 オーストラリア 104名 カナダ 79名 アイルランド 24名 ニュージーランド 22名 フィリピン 19名 ベトナム 15名 アフガニスタン 13名 韓国 10名 フィンランド 9名 中国 7名 オランダ 5名 スウェーデン 4名 ドイツ 4名 台湾 4名 アラブ首長国連邦 3名 インドネシア 3名 スペイン 3名 スロバキア 3名 ポーランド 3名 イギリス 2名 イタリア 2名 シンガポール 2名 デンマーク 2名 ハンガリー 2名 フランス 2名 リトアニア 2名 スリランカ 1名 タイ 1名 チェコ 1名 トルコ 1名 ノルウェー 1名 ベルギー 1名 マレーシア 1名 ※ 2022 年度実績(一部オンライン留学を含む)
派遣留学生
受け入れ留学生(外国人) 中国 465名 韓国 35名 台湾 28名 ベトナム 17名 マレーシア 16名 イギリス 13名 デンマーク 11名 スペイン 9名 ドイツ 8名 フランス 7名 アメリカ 6名 タイ 5名 ベルギー 5名 イタリア 4名 インドネシア 4名 オランダ 4名 チェコ 4名 ミャンマー 4名 フィンランド 3名 アイルランド 2名 オーストラリア 2名 カナダ 2名 ブルキナファソ 2名 ポーランド 2名 アルメニア 1名 インド 1名 エスワティニ王国 1名 ザンビア共和国 1名 スリランカ 1名 スロバキア 1名 トルコ 1名 ハンガリー 1名 バングラデシュ 1名 ブルガリア 1名 マラウイ 1名 メキシコ 1名 リトアニア 1名 ロシア 1名 ※ 2022 年度実績(一部オンライン留学を含む)
Ryukoku University 2024 70
Speaking Partner Program

スピーキングパートナー プログラム
龍谷大学で学ぶ各国・地域からの留学生と日本人など学 生が積極的に交流する機会を提供することで、キャンパ ス内の国際交流を活性化。お互いの語学力を高め合える ことはもちろん、それぞれの文化に触れながら語り合う ことで幅広い視野を養えます。

Global Career Challenge Program

グローバル・キャリア・ チャレンジプログラム
グローバルな社会で活躍したいと考える学生を対象に、 グローバル企業や国際機関で活躍するために必要な知識 や能力を養うために、学生の学びの意欲を喚起し、主体的 に学業に取り組む姿勢、留学や語学学習等に積極的に取 り組む姿勢を育んでいます。
Global Commons グローバルコモンズ
日本人学生や海外からの留学生が集う、マルチカル チャー、マルチリンガルな学びの空間です。スピーキング ブースやランゲージスタディエリア、マルチリンガルス タジオなど、多様な学びに対応しています。留学や語学試 験・学修に関する資料も揃っています。
Ryukoku University 2024 71
龍谷大学の留学制度
交換留学
本学の協定校(45ヶ国・地域136大学・機関)と、相互 に派遣・受け入れを行う制度です。半年間または1年 間の留学期間中、大学によっては、宿泊費の免除、奨 学金支給があります。また、留学先で修得した単位は 認定対象となります。
本学の通常学費免除※1 /留学先大学の学費免除
大学によって宿泊費の免除や奨学金の支給
留学中の単位は卒業単位として認定可能
※1:留学在籍料と諸会費のみ納入が必要です。ただし、国際学部 グローバルスタディー ズ学科の学生は通常学費の納入が必要です。
留学までの流れ
STEP1 交換留学募集要項で留学先を調べる
STEP2 語学試験(TOEFL®・IELTS™)の受験
STEP3 願書等必要書類の提出
STEP4 オリエンテーション、各種手続き
STEP5 留学(マンスリーレポート提出)
STEP6 報告書・レポート作成、単位認定手続き
RIP留学※2
龍谷大学の海外拠点を活用した、独自の留学プログラムです。
英語を学修しながら、多様な文化が共存する海外でのボラン ティア活動(Community Service Learning)と英語による講


義を有機的に組み合わせることで、英語運用能力の向上とと もに、幅広い視野を身につけ、柔軟な発想を育んでいます。
安心のサポート体制
留学中の単位は卒業単位として認定可能
成績優秀者には奨学金を給付
留学までの流れ
STEP1 説明会への参加
STEP2 プログラムへの応募
STEP3 面接・レポートなどによる選考
STEP4 オリエンテーション、事前授業
STEP5 留学(現地スタッフによるサポート)
STEP6 報告会にて留学成果の報告
※2:国際学部 グローバルスタディーズ学科の学生は対象外です。
Ryukoku University 2024 72
私費留学※2
自分で留学先を決め、希望する大学(原則として学士号 を取得できる4年制大学または大学付属語学学校)に願 書を提出、入学許可を得た後、所属学部の承認と龍谷大 学学長の許可を受け、半年間または1年間留学します。
本学の通常学費免除※3
留学中の単位は卒業単位として認定可能
※2:国際学部 グローバルスタディーズ学科の学生は対象外です。
※3:留学在籍料と諸会費のみ納入が必要です。
短期留学
夏期休暇や春期休暇を利用して行う海外留学制度で す。大学の「短期留学プログラム」または個人で留学先 を決定し短期留学する、2種類の方法があります。短期 間で語学勉強+αの留学を希望する方に人気です。
短期間で語学勉強+α
留学中の単位は卒業単位として認定可能
留学までの流れ 主な短期留学
STEP1 留学先を調べる、費用を見積もる 留学先へ願書を提出、受入通知
STEP2 留学申込み 学部で書類選考・面接実施、留学承認
STEP3 学内手続き・留学承認 留学許可書発行、留学決定、学費免除手続き
STEP4 渡航手続き、出発
STEP5 留学先で学修、現地で単位取得
名称 国 対象学部 単位認定
海外英語研修 アメリカ オーストラリア 他 全学部生 (1年次~2年次) 2単位
海外中国語 研修講座 中国 文・経済・経営・法・ 政策・国際(国際文 化)学部生の2年次 生以上 2単位 グローバル人材 育成プログラム シンガポール タイ など 全学部生 無
海外研修 アメリカ カナダ イギリス オーストラリア アイルランド
STEP6 帰国・帰国報告書作成、単位認定
留学の経済的支援
RIP留学への奨学金
交換留学奨学生
※ 国際学部グローバルスタディーズ学科は対象外です。 別途、奨学金制度があります。
私費留学奨学生
○5-week Program 10 万円
○Semester Program 30 万円
国際文化
交流研修
文学部3年次以上の 正規学生 (夏期のみ) 4単位 英語コミュニケー ションコース生 (夏期・春期)
学生が自主的に行う海 外での国際文化交流に 対して単位を認定する ものです。
文学部1年次以上の 正規学生 2-8単位
※その他、国際学部では、国際学部生を対象とした留学プログラムがあります。各自が希望する研修 先に留学する自己応募短期留学制度があります。 ※上記のプログラム以外には、単位認定のない「友好セミナー」などがあります。
プログラム 修了後
5-week Program Semester Programそれぞれ の成績優秀者(最大2人)
本学の学費免除/留学先大学の学費免除 ※ 留学在籍料と諸会費のみ必要
本学の学費免除 ※ 留学在籍料と諸会費のみ必要
私費派遣留学生奨励奨学生 ○給付 15 万円
留学時 本学から交換留学する学生
留学時 本学から私費留学する学生
留学時
所属の学部教授会から私費派遣留学生として 承認された者。自己応募制(応募しなければ選 考の対象となりません)。
Ryukoku University 2024 73
コロナ禍での語学学習
レジデント・サポーターを務めながら 異文化理解と語学力アップをめざす
橋下 音央さん 国際学部 国際文化学科 2年生 (京都府立北嵯峨高等学校出身)
フィンランドへの留学に備えレジデント・サポーターを務めています。留学生寮でレ ジデント・サポーターとして寝食を共にし、彼らの学生生活を1年間サポートする役 割です。学業との両立は難しいものの、苦労より学びを得られる喜びが勝り毎日がと ても充実しています。実際に寮に住むようになって、英語力の向上はもとより異文化 への理解も深まっていると実感します。彼らの学修に対する姿勢やグローバルな視 野など、学びの多い刺激的な生活は、コロナ禍で留学を叶えにくい現状におけるモチ ベーションの維持にもつながっています。今後も留学生との交流をとおして語学力 を磨き、来たる留学の実現に向けて着々と準備をすることができています。

コロナ禍での留学体験記
現地学生から教わったのは、学ぶ意欲と挑戦心 (デンマーク/オーフス大学)

山内 美樹さん 国際学部 グローバルスタディーズ学科 3年生 (兵庫県立川西明峰高等学校出身)
デンマーク最高学府のひとつであるオーフス大学を留学先に選んだのは、あえて厳し い環境に身を置き実力を試したいと考えたからです。実際に現地学生の学習意欲は非 常に高く、彼らのほとんどが第二言語である英語を母語であるかのように流暢に話し ます。現地学生や他国留学生との交流をとおして異文化への理解が深まると同時に、 年齢にとらわれない学びに貪欲な姿勢にも刺激を受けました。また、学生主体で進む グループワークやディスカッション中心の授業形態や、学生が教員を評価するシステ ムなど、日本とは違う学習環境に驚く一方で、自国の魅力も再認識しています。渡航 の延期により交換留学期間の半分はオンライン授業となったものの、それもコロナ禍 だからこその貴重な体験だったのかもしれません。大学や周囲の協力で現地留学が実 現したときは言葉にできないほどの感動を覚えました。留学中の経験をキャリア形成 に活かし、帰国後もさまざまなことに挑戦し続けていきたいと思います。
Ryukoku University 2024 74
学生交換協定校 45 ヶ国・地域 136 の大学・機関
タイ
▲ タイ国立開発行政研究院
▲ カセサート大学
●▲ タマサート大学
●▲ シーナカリンウィロート大学
●▲ チェンマイ大学
● チュラロンコン大学
● アサンプション大学
▲パンヤピワット経営大学
▲ バンコク大学
東ティモール
●▲ 東ティモール国立大学
シンガポール
▲ ナンヤン・ポリテクニック
ミャンマー
▲ マンダレー工科大学
バングラデシュ
▲ ユヌスセンター
●▲ ダッカ大学
キルギス
▲キルギス共和国国立科学アカデミーB.ジャムゲルチノワ
記念歴史・考古・民族学研究所
インド
▲ THE INSTITUTE FOR DEVELOPMENT AND COMMUNICATION
●▲ デリー大学
モンゴル
▲ モンゴル国立大学
フィリピン
●▲ フィリピン大学ディリマン校
国際交流一般協定校 62 ヶ国・地域 214 の大学・機関
セルビア
●▲ ベオグラード大学
イタリア
●▲ ローマ・ラ・サピエンザ大学
▲ バーリ工科大学
● ボローニャ大学
● サレルノ大学
▲ トリノ大学都市イベント研究センター
●▲ フォッジャ大学
●▲ ヴェネツィア・カ・フォスカリ大学
●▲ サッサリ大学
サンマリノ
●▲ サンマリノ共和国大学
ハンガリー
▲ ペーチ大学人文学部アフリカ研究センター
●▲ エトヴェシュ・ロラーンド大学
●▲ 文藻外語大学 ▲ 南華大学 ●▲ 国立中正大学 ▲ 国立成功大学 社会科学院
● 東海大学
● 長庚大学
● 国立中央大学
▲ 国立台湾大学 海洋研究所
▲ 国立中興大学 国際政治研究所
●▲ 国立台北科技大学工程学院分子科学・
有機高分子学部
●▲ 佛光大学
▲ 国立中山大学
●▲ 大葉大学
●▲ 国立高雄科技大学
▲ 国立成功大学
大韓民国
●▲ 東国大学校
●▲ 東亞大学校
▲ 成均館大学校
▲ 朝鮮大学校
▲ 全南大学校 自然科学部
▲ 韓国教員大学校第2大学校
▲ 慶煕大学校外国語大学校
▲ 江原大学校社会科学大学校
▲ 韓国外国語大学校アフリカ研究所
▲ 祥明大学校師範大学(教育学部)
▲ 韓瑞大学校
●▲ 中央大学校
●▲ カトリック大学校
●▲ 京畿大学校
▲ 全北大学校
● 祥明大学校
▲ 延世大学校北朝鮮研究所
▲ 国立忠北大学校農業生命環境大学
ブータン
▲ ロイヤル・ティンプー大学
ネパール
▲ ルンビニ仏教大学
インドネシア
▲ ハサヌディン大学
▲ ウィジャタマ大学
●▲ インドネシア大学
ベトナム
▲ ダナン大学
●▲ ハノイ工科大学ベトナム日本国際技学院
●▲ ホーチミン市外国語情報技術大学
▲ クイニョン大学
●▲ ハノイ工業大学技学院
● ハノイ大学
マレーシア
●▲ マラヤ大学
●▲ マレーシア工科大学
●▲ テイラーズ大学
▲ サンウェイ大学
アルメニア
●▲ エレバン国立大学
アメリカ
●▲ 米国仏教大学院(IBS)
▲ 仏教研究センター(BSC)
●▲ カリフォルニア大学デービス校
●▲ アンティオーク カレッジ
▲ アンティオーク大学
▲ マウントフッドコミュニティカレッジ
▲ ジョージア大学
● アリゾナ州立大学
▲ ハワイ大学ヒロ校
▲ パデュー大学カルメット校
●▲ マサチューセッツ大学ボストン校
▲ ジョージア州立大学
▲ アルバニー州立大学
▲ ポートランド州立大学
▲ ポートランド州立大学パブリックサービス研究・実践センター
▲ カリフォルニア大学バークレー校東アジア研究所
●▲ カリフォルニア州立大学ノースリッジ校
▲ 東カロライナ大学
▲ ミッドミシガンカレッジ
▲ 南カリフォルニア大学インターナショナルアカデミー
▲ 西ミシガン大学
▲ アリゾナ大学
▲ グアム大学
● 南ミズーリ州立大学
● 東テネシー州立大学
● アイダホ大学
● ハワイ大学マノア校
▲ カリフォルニア大学リバーサイド校
▲ デューク大学
カナダ
●▲ キングス・ユニバーシティ・カレッジ
●▲ カルガリー大学
●▲ クワントレンポリテクニック大学
●▲ メディシン・ハット・カレッジ
● ランガラカレッジ
● レイクヘッド大学
● ヒューロン・ユニバーシティ・カレッジ
▲ アルバータ大学
●▲ フレーザーバレー大学
▲ サスカチュワン大学
メキシコ
▲ メキシコ自治都市大学
●▲ プエブラ栄誉州立自治大学
▲ レギオモンタナ大学
キューバ
●▲ハバナ大学
ブラジル
▲ アマゾニア連邦農牧大学
ペルー
▲ カジェタノエレディア大学
▲ サウス アンド シティーカレッジ バーミンガム
● セントラルランカシャー大学
● イースト・アングリア大学
● バンガー大学
● オックスフォード・ブルックス大学
▲ カーディフ大学
● ハートフォードシャー大学
▲ ブラッドフォード大学
アイルランド
● ユニバーシティ・カレッジ・コーク
フィンランド
●▲ ユヴァスキュラ応用科学大学
●▲ オーボアカデミー大学
●▲ ヴァーサ大学
● 東フィンランド大学
▲ ラハティ応用科学大学
ベルギー
●▲ ゲント大学
●▲ モンス大学
ポーランド
●▲ ワルシャワ経済大学
●▲ カトヴィツェ経済大学
●▲ ヤギェウォ大学
▲ ニコラウス・コペルニクス大学
フランス
▲ カーン大学
●▲ リヨン第3大学
●▲ リールカトリック大学
●▲ エクス=マルセイユ大学
●▲ トゥール大学
ドイツ
▲ ベルリン科学技術大学
●▲ ブレーメン応用科学大学
●▲ ロイファナ大学リューネブルク校
経営・経済学部生産過程革新学科
● デュースブルグ・エッセン大学
▲ ドルトムント工科大学
●▲ パーダーボルン大学
スペイン
●▲ バレンシア大学
●▲ バルセロナ自治大学
▲ セビリア大学
●▲ サン・アントニオ・ムルシア・カトリック大学
スロバキア
● コメンスキー大学
スウェーデン
● リネウス大学
●▲ クリスチャンスタード大学
デンマーク
●▲ オールボー大学
●▲ 南デンマーク大学
● オーフス大学
●▲ コペンハーゲン大学 人文学部
オランダ
●▲ ラドバウド大学
●▲ ロッテルダム応用科学大学
●▲ フォンティス応用科学大学
●▲ ウィンデスハイム応用科学大学
●▲ サキシオン応用科学大学
ギリシャ
●▲テッサロニキ・アリストテレス大学
ルーマニア
●▲ ティミショアラ西大学
チェコ
●▲ オストラヴァ大学
●▲ マサリク大学
エストニア
●▲ タリン大学
ラトビア
▲ ダウガフピルス大学
ブルガリア
▲ ブルガス自由大学
リトアニア
●▲ ヴィリニュス大学
ウクライナ
● キーウ(キエフ)大学
ロシア
▲ モスクワ大学
● モスクワ大学アジア・アフリカ学院
ポルトガル
●▲ リスボン大学高等技術院
スイス
▲ ザンクトガレン応用科学大学
▲ チューリッヒ大学
ノルウェー
●▲ ノード大学
クロアチア
▲ リエカ大学
トルコ
●▲ アンカラ大学
▲ イスタンブール大学
イラン
▲ コム宗教大学 ▲ テヘラン大学 イスラエル
▲ ベイト・ベール大学
南アフリカ共和国
▲ クワズール・ナタール大学
▲ プレトリア大学 人文学部
ナイジェリア ▲ イグビネディオン大学オカダ
▲ クワラ州立大学 日本言語文化インスティチュート
▲ アブジャ大学
シエラレオネ
▲ シエラレオネ大学
▲ ジャラ大学
アンゴラ共和国
●▲ アゴスティーニョネト大学
タンザニア
▲ ステラ・マリス・ムトワラ・ユニバーシティカレッジ
マラウイ
●▲ マラウイ大学
ケニア
▲ マセノ大学
● 学生の交換協定を結んでいる「 学生交換協定校」45ヶ国・地域136大学・機関
▲ 研究交換・交流に関する協定を結んでいる「国際交流一般協定校」62ヶ国・地域214大学・機関 ※2023年3月現在(再締結交渉・手続き中の協定など含む)
中国 ▲ 西安交通大学 外国語学院 ▲ 武漢大学中国三至九世紀研究所 ▲ 華東政法大学 政治学与公共管理学院 ▲ 華東政法大学 政治学研究院 ▲ 中国蔵学研究中心 ▲ 華東師範大学偏微分方程中心 ▲ 華中師範大学 ▲ 寧波大学 ●▲ 南京大学金陵学院 ●▲ 中央民族大学 ●▲ 瀋陽大学 ▲ 瀋陽農業大学 ▲ 青島農業大学 ▲ 旅順博物館 ●▲ 嶺南大学 ● 同済大学 ● 上海師範大学 ● 中国人民大学 ▲ 中国人民大学仏教と宗教学理論研究所 ● 大連外国語大学 ● 香港理工大学 ● 雲南大学 ▲ 西南民族大学 ▲ 湖南財政経済学院 ▲ 重慶工商大学 ▲ 広東外語外貿大学 ▲ 瀋陽建築大学 ▲ 南京郵電大学 台湾 ▲ 中華佛学研究所 ●▲ 国立台湾師範大学 ●▲ 淡江大学 ●▲ 東呉大学 ●▲ 国立台湾科技大学 ●▲ 逢甲大学
●
▲
クライストチャーチポリテクニック工科大学 ▲ ワイカト大学 ▲ リンカーン大学 イギリス ●▲ ミドルセックス大学 ▲
▲
●▲ ニューキャッスル大学
マレーシアサインズ大学 オーストラリア ●▲ RMIT大学
サザンクロス大学 ●▲ カーティン大学 ● マードック大学 ● ディーキン大学 ●▲ オーストラリアカトリック大学 ▲ 西シドニー大学 ニュージーランド ▲
カンタベリークライストチャーチ大学
ケンブリッジ大学ヒューズホール
Ryukoku University 2024 75
More Actions

Ryukoku University 2024 76
More Results
龍谷大学のキャリアサポート
大学生活で経験することはすべて、 あなたの将来につながる大切な財産となります。 学業はもちろん、さまざまな人との出会いや、 キャリア支援イベントへの積極的な参加が、 あなたの可能性をどんどん広げていきます。
Ryukoku University 2024 77
キャリア支援スケジュール
龍谷大学では、生涯をとおして自 分らしい生き方を実現するための力や考え方を早期から育む「キャリア教育」と、主体 的な進路選択を多様なプログラムと個人面談でサポートする「進路・就職 支 援」を二本柱として支援に取り組んでいます。 多様化する社会や就職環境の変化に柔軟に対応した、きめ細やかで丁寧な支援を対面・オンラインを併用して提供し、 一人ひとりの夢や目標の実現を全面的にバックアップします。
キャリア支援プログラム
※短期大学部は、2年間の各学年を前期・後期のセメスターに分け、独自のプログラムでキャリア支援を行っています。

1 年次 2 年次 3 年次 4 年次
自分を知って、 大学生活の目標を 見つける。
■ 個別相談
経験を積み、 未来の自分に役立てる。
■ 教養教育科目特別講義(キャリア入門)[正課科目(2単位)]
■ 資格取得・就職支援のためのキャリア支援講座
■ RYUKOKUキャリア・スタート・プログラム
■ グローバル・キャリア・チャレンジプログラム(GCCP)
■ 学生キャリアサポーター
■ 正課科目における
キャリア教育の実施
■ アセスメントテスト
「大学生基礎力レポートⅠ」

「GPS-Academic」
準備をすすめ、 自己の進路と向き合う。
恐れずに挑戦し、 未来をつかみ取る。
グローバルに展開している企業・ 国際機関の仕事や実情を知ると ともに、グローバルな組織で求 められる知識や能力とは何かを 学ぶ1・2年次生が対象の学部横 断型プログラムです。

■ 2年次生対象キャリアセミナー
■ 個人模擬面接
■ オンライン選考用個別BOX
■ 進路・就職ガイダンス
■ 自己PR作成講座
■ インターンシップ対策セミナー
■ エントリーシート・履歴書作成講座
■ 就職活動マナー講座
■ 筆記試験ガイダンス
■ 面接対策講座
■ 先輩学生の体験発表会


■ 学内業界研究会
■ 学内企業研究会

■ 公務員ガイダンス
■ 公務員仕事理解セミナー
■ アセスメントテスト
「GPS-Academic」
■ U・Iターン就職セミナー
■ U・Iターン就職ガイダンス& 個別相談会
正課科目における キャリア教育の実施 2
全学部において、キャリア教育を実 施しています。低年次向けキャリ ア形成読本を活用し、大学での学 びや支援、参加できる活動の紹介 や目標設定などを行い、学生のキャ リアプランニングを促しています。
本番を想定した模擬面接を行い ます。改善点やアピールポイン トを見つけ、本番で力を発揮で きるように指導します。
18府県と就職支援協定を締結 し、地方就職を積極的にサポー トしています。「U・Iターン就職 セミナー」など、就職状況の説明 や地元Uターン情報の提供、個別 相談会を実施しています。
1
グローバル・キャリア・ チャレンジプログラム(GCCP)
U・Iターン就職セミナー 4
個人模擬面接 3
2
1 4 3
Ryukoku University 2024 78
オンライン選考用個別BOX
万全のキャリア支援体制
キャリアカウンセラー
学部担当制で、 全学生をサポート。 1
学部担当カウンセラーが継続的に進路・就職支援を行います。一人ひ とりの興味や将来像にあわせた進路選択をバックアップします。
国家資格をもつ経験豊富な キャリアカウンセラーが在籍。
業界事情や採用のポイントなど、国家資格をもつキャリアカウンセ ラーから実践的なアドバイスが受けられます。
エントリーシートや履歴書の 書き方、模擬面接も丁寧に指導。 3
個性や強みを把握したうえで、自らをアピールする方法、社会で通用 する自己表現力を高める方法をお伝えします。


学外での就職活動拠点
大阪梅田キャンパス
JR大阪駅桜橋口から徒歩約4分
の好立地。各キャンパスと同じ
条件でPCや無線LANの利用な どができます。模擬面接や進路・ 就職相談、エントリーシートの チェックなど、大阪で就職活動 をする学生をサポートします。
【住所】
大阪市北区梅田2-2-2
ヒルトンプラザウエストオフィスタワー14階
【アクセス】
●JR「大阪」駅桜橋口より徒歩約4分 ● 大阪メトロ四つ橋線「西梅田」駅3番 出口すぐ、地下直結
キャリアステーション
with H エイチワンティ 1T
野村不動産株式会社が運営する サテライト型シェアオフィスH1T と提携し、学生の就職活動拠点 を全国約30拠点整備。
休憩可能なオープンスペースや、 オンライン面接などに便利な個 別ボックスを備えた施設です。首 都圏やU・I・Jターン先でのオン ライン面接、企業説明会など、 就職活動時に利用できます。

学生の就職活動状況把握率
高い進路・就職状況把握率 99.4 %
キャリアセンターでは、卒業年次生の応募企業や選考通過状況などを 確認し、活動が停滞している学生にはメールや電話でアプローチして います。個別面談のなかで、共に課題を確認して解決策を探り、個々
の適性に合った求人情報も継続的に提供。満足度の高い進路・就職決 定まで、親身になってサポートします。
進路・就職決定過程の履歴を蓄積
Web履修登録時に進路・就活状況を把握 (企業選びの志向性、不安要素、弱点・課題)
活動が停滞している学生の把握
就活状況データに基づく個別面談の積み重ねによる就職支援。
段階を追って信頼関係を構築し、相談窓口に来やすい環境を整備。
● 個々のもつ力の抽出・確認・自己効力感向上。
● 進路・就職決定に向けた課題特定と行動計画づくり。
● 求人情報の提供により行動を喚起。
2021年度求人掲載数 約 15, 800 社
龍谷大学キャリアセンターに寄せられた企業などからの求人情報をは じめ、インターンシップの募集情報や先輩たちの就職活動体験談、龍谷 大学限定のとっておき情報などがチェックできる学生専用サイトです。
U・Iターン就職支援
自治体との就職に関する協定実績 18 府県
龍谷大学では18府県と就職支援協定を締結し、地方就職を積極的に サポートしています。具体的にはオンラインによる「U・I ターン就職 セミナー」の開催があり、就職状況の説明や地元Uターン情報の提供、 個別相談会を実施しています。
● 北陸地方2 県(石川県・福井県)
● 中部地方2 県(長野県・三重県)
● 近畿地方1 府1 県(京都府、滋賀県)
● 中国地方5 県(鳥取県、島根県、広島県、岡山県、山口県)
● 四国地方4 県(徳島県、香川県、愛媛県、高知県)
● 九州地方3 県(福岡県、熊本県、鹿児島県)
キャリア形成補助金制度
龍谷大学親和会(保護者会)の支援により、キャリア形成に資する活動(イ ンターンシップやオープン・カンパニー、U・Iターン活動など)にかかる 交通費や宿泊費を一定の条件を満たす場合、上限50,000円まで補助して います。学生は費用を心配することなく活動に取り組むことができます。
▼
2
※2021年度実績
就職情報システム「龍谷キャリアナビ(龍ナビ)」
龍谷
Ryukoku University 2024 79
学内合同企業研究・説明会
年間約380社の企業・団体が参加し、 学内合同企業研究・説明会を開催しています。
企業の声を直接聞き、「働くこと」の実感をつかみます。
2022年度は2月にオンライン、3月に対面で計9日間開催し、 2023年3月末時点で、延べ約4,100名の学生が参加しました。こ
れ以外にも、就活状況や企業の採用動向をふまえ、学生と企業の マッチング機会を創出しています。
約 380社
公務員就職支援
主な参加企業
株式会社安藤・間
凸版印刷株式会社
株式会社イシダ 西日本旅客鉄道株式会社(JR西日本) 株式会社伊藤園 日本電産株式会社※
大阪瓦斯株式会社(大阪ガス株式会社) 日本食研ホールディングス株式会社
株式会社京都銀行
日本通運株式会社
近畿日本鉄道株式会社 日本放送協会(NHK)
月桂冠株式会社 フジテック株式会社
株式会社SCREENホールディングス 富士フイルムビジネスイノベーション株式会社 セキスイハイム近畿株式会社 株式会社堀場製作所
積水ハウス株式会社 株式会社村田製作所
象印マホービン株式会社 吉本興業株式会社
大王製紙株式会社 株式会社淀川製鋼所
タカラスタンダード株式会社 株式会社LIXILグループ
東海旅客鉄道株式会社(JR東海)株式会社りそなホールディングス 東洋シヤッター株式会社 株式会社ロッテ
公務員を志望する学生が集中して試験対策に取り組み、効率的に公務員の仕事理解を深められるよう、多岐にわたる支援を行っています。 公務員試験対策に信頼と実績のある有名予備校等と提携して公務員講座を開講したり、公務員として働く方々や公務員試験に合格し た卒業年次生の協力を得たりしながら、公務員を志望する学生のニーズに沿ったガイダンス・セミナーなどを開催しています。これらは 全て1年次生から参加でき、早期から公務員就職に向けた準備を行うことができます。
ガイダンス
有名予備校等の講師を招聘して開催する公務員 志望者向けのガイダンスです。2022年度は、公 務員採用の動向と対策、公務員の種類と職種研 究、民間企業との併願、面接対策と自己PR・志 望動機の書き方等をテーマにオンラインで3回開 催しました。
仕事理解セミナー
実際に公務員として働いている方をお招きし、仕 事のやりがい、心構え、業務内容、求める人物像 等についてお話しいただくセミナーです。2022年 度は、12団体の方々にご協力いただき、11月に 10日間にわたりオンラインで開催しました。
キャリア支援講座
合格者による体験発表会
公務員試験に合格した卒業年次生にリアルな体験 談を聞くセミナーです。試験対策、勉強方法、モチ ベーション維持の秘訣など、公務員試験を乗り越 えた先輩から直接アドバイスを受けることができま す。2022年度は、12月に4日間にわたりオンライ ンで開催しました。
一生の仕事につながるスキルアップから専門資格まで一人ひとりの夢の実現をサポートする資格取得・就職支援講座を開講しています。 公務員講座など複数の講座では、対面形態とオンライン形態を自由に選択でき、時間や場所を気にせず受講できます。信頼と実績のあ る有名予備校等による講座を龍谷大学生のための価格で提供します。
就職対策講座
公務員講座
エアライン就職対策講座
筆記試験対策講座(SPI・玉手箱など)
※開講講座は年度により変更する場合があります。
語学系講座
TOEIC® Listening&Reading Test対策講座 ・700点対策コース
・650点対策コース
・550点対策コース
・470点対策コース
※TOEIC is a registered trademark of Educational Testing Service(ETS).This product is not endorsed or approved by ETS.
資格系講座
宅地建物取引士講座
旅行業務取扱管理者講座
社会福祉士国家試験講座
学内合同企業 研究・説明会 参加企業年間
Ryukoku University 2024 80
※2023年4月1日より「ニデック株式会社」に社名変更
RYUKOKU キャリア・スタート・プログラム
本学では、学生の自立とキャリア形成を支援する実践的な教育プログラムとし て全学共通のRYUKOKUキャリア・スタート・プログラムを展開しています。こ
れは、教養教育科目の受講と企業・団体などでの実習を組み合わせた本学独自 の教育プログラムです。
RYUKOKU キャリア・スタート・プログラム
実習前 +
実習直前・実習・実習後
「教養教育科目特別講義(キャリア入門)」 「キャリア実習・実習指導」
■ プログラムの流れ
キャリア形成に関連する現代社会に おける諸課題やそれらを取り巻く状 況を、労働、人権、法律、DX、グロー バルなどのさまざまな視点から学ぶ。
[内容]
「教養教育科目特別講義(キャリア入門)」
(全15回開講)
[単位]
2単位
実習前の 目標設定と準備
グループワークを中心に、実習に参 加する目的を明確にし、実習先の業 界や企業研究などを行う。
企業や自治体などで 就業体験 大学が協定を締結する企業・団体 で、5日間以上の就業体験を行う。

実習の振り返りを行い、 報告会で自身の体験を発表 グループワークを中心に実習の振り 返りを行い、各クラスの代表が報告 会で発表を行う。
[内容]
「キャリア実習・実習指導」
直前学修(7月)+実習(夏期休暇期間中 実働5日間以上)+事後学修(9月)
[単位]
2単位
講義のみを受講することもできます。
各回のテーマに応じて、その分野の専門教員が講義を担当します。卒業生を含む社会人の方から話を 聞く機会もあり、受講することで自分の将来のキャリアイメージを膨らませることができます。
2022年度受入企業・団体
社・団体
■ 参加のメリット
①新たな学修意欲を喚起するきっかけになる
94. 9 % インターンシップ実習満足度
②自分の職業適性や将来設計について考える機会となり、
主体的な進路選択や高い職業意識が醸成される
③社会人として必要な能力を高め、自主的に考え行動できる力を養える 92. 4 % プログラム全体に対する満足度
大学と企業・団体との協定による独自の教育プログラム。
建設業 8 製造業 17 卸売業 9 小売業 11 金融業 2 不動産 2 運輸業 3 サービス業 19 情報通信業 4 福祉 3 教育 1 公務員 6 85
事前学修 直前学修 実習 事後学修 キャリアプランニング (人生設計)を 実践できる力を醸成
1
Step
Step 2
Pick Up Pick Up Ryukoku University 2024 81
Step 3
進路・就職データ
進路・就職決定率 96.7%
※ 進路・就職決定率は、就職・進学希望者を母数に算出。
33 .4
2017~2021年度文学部臨床心理学科卒業生の就職実績を記載)
就職先満足度 94.9 %
※ 本学 2021年度「就職活動アンケート調査」より。(大いに満足、満足と答えた割合)
14.4
13 .7%
0 20 40 60 80 100 0 20 40 60 80 100 0 20 40 60 0 20 40 60
文学部 経済学部
社会学部 農学部 その他 8.9 % 福祉 4.9% 宗教 1.1% 教育 11.9% 公務員 5.9 % 情報通信業 7.5% サービス業 15.6% 土木・建設業 3.6 % 不動産 1.6 % 運輸業 2.3 % 金融業 6.2% 卸売業 6.3% 小売業 16.2% 製造業 7.8% エネルギー 0.2% 業種 内訳 その他 3.4 % 福祉 1.2% 教育 3.4% 公務員 9.2 % 情報通信業 9.9% サービス業 21.0% 土木・建設業 7.6 % 不動産 4.2% 運輸業 1.5% 金融業 9.9% 卸売業 7.3% 小売業 12.2% 製造業 9.2 % 業種 内訳 業種 内訳 その他 2.9% 福祉 16.7% 教育 4.9% 公務員 6.5 % 情報通信業 4.5% サービス業 13.0% 土木・建設業 3.1 % 不動産 2.6% 運輸業 2.4% 金融業 6.5% 卸売業 11.0% 小売業 16.3% 製造業 8.8 % エネルギー 0.6 % 農林・水産・鉱業 0.2 % 業種 内訳 その他 3.7% 農林・水産・鉱業 0.2 % 福祉 1.6% 教育 1.8% 公務員 6.1 % 情報通信業 9.3% サービス業 18.1% 土木・建設業 6.9% 不動産 3.2% 運輸業 2.6% 金融業 8.7% 卸売業 13.4% 小売業 11.2% 製造業 13.0% エネルギー 0.2% 業種 内訳 その他 6.7 % 福祉 2.1% 教育 3.4% 公務員 4.0 % 情報通信業 2.7% サービス業 9.8% 土木・建設業 4.3% 農林・水産・鉱業 4.0% 運輸業 2.4% 金融業 8.0% 卸売業 9.2% 小売業 27.8% 製造業 15.6% 大企業 29.7% (1,001人以上) 公務員 8 .8 % (公立教員含む) 小企業
% (100人未満) 中企業
% (100人以上) その他
(非営利・福祉など)
業種 内訳 その他 3.1% 福祉 1.3% 宗教 0.3% 教育 4.4% 公務員 4.4 % 情報通信業 8.2% サービス業 17.5% 土木・建設業 3.4% 不動産 4.4% 運輸業 7.0% 金融業 6.4% 卸売業 12.6% 小売業 13.4 % 製造業 13.1% エネルギー 0.5% Ryukoku University 2024 82
政策学部 国際学部
(2021年度卒業生実績。心理学部は2023年4月新設のため、
0 20 40 60 80 100 0 20 40 60 80 100 0 20 40 60 0 20 40 60 0 20 40 60 国家公務員 合格者数 66 名 警察・消防 合格者数 90 名 地方公務員 合格者数 140 名 公立学校教員 採用試験 合格者数 156 名 法学部 経営学部 短期大学部 心理学部 先端理工学部 業種 内訳 〈社会福祉学科〉 その他 13.8% 福祉 55.2% 教育 3.4% 公務員 3.4 % 製造業 6.9% サービス業 10.4% 小売業 6.9% 業種 内訳 〈こども教育学科〉 その他 2.2% 教育 48.3% 公務員 7.9% サービス業 1.1% 福祉 40.5% 業種 内訳 〈大学院 理工学研究科〉 教育 2.9% 公務員 1.1 % 情報通信業 16.7% サービス業 6.9% 土木・建設業 7.5 % 金融業 0.6% 卸売業 1.1 % 小売業 0.6 % 製造業 61.5 % エネルギー 1.1% 業種 内訳 〈理工学部〉 その他 0.5 % 農林・水産・鉱業 0.3% 福祉 0.3% 教育 4.6% 公務員 2.9 % 情報通信業 21.6% サービス業 21.8% 土木・建設業 6.5 % 不動産 1.1 % 運輸業 0.3% 金融業 2.4 % 卸売業 4.0 % 小売業 5.1 % 製造業 27.5 % エネルギー 1.1% 業種 内訳 その他 3.2 % 福祉 1.2% 教育 2.6% 公務員 20.3 % 情報通信業 7.0% サービス業 14.0% 土木・建設業 4.9 % 不動産 5.5% 運輸業 2.9% 金融業 6.4% 卸売業 9.6% 小売業 12.8% 製造業 9.3 % エネルギー 0.3 % 業種 内訳 その他 1.9 % 福祉 6.9% 宗教 0.6% 教育 2.2% 公務員 5.3 % 情報通信業 8.1% サービス業 20.2% 土木・建設業 3.7 % 不動産 3.4 % 運輸業 1.9% 金融業 5.6 % 卸売業 10.6% 小売業 20.6% 製造業 9.0 % 業種 内訳 農林・水産・鉱業 0.2 % その他 2.8 % 福祉 1.2% 教育 1.7% 公務員 1.7 % 情報通信業 8.8% サービス業 18.1% 土木・建設業 2.8% 不動産 4.3% 運輸業 3.1% 金融業 13.5 % 卸売業 13.1% 小売業 14.5% 製造業 14.0% エネルギー 0.2% ※先端理工学部は2020年4月開設のため、理工学部の就職状況を掲載。 ※2019 2021 年度修了生実績 Ryukoku University 2024 83
専門資格・教員免許状等
取得できる資格
グローバルスタディーズ学科数理・情報科学課程知能情報メディア課程電子情報通信課程 機械工学・ロボティクス課程 応用化学課程 環境生態工学課程 社会学科 コミュニティマネジメント学科 現代福祉学科 生命科学科 食料農業システム学科食品栄養学科農学科社会福祉学科こども教育学科 哲学専攻教育学専攻日本史学専攻東洋史学専攻仏教史学専攻文化遺産学専攻
課程・資格
●
社会福祉士国家試験受験資格 ●
精神保健福祉士国家試験受験資格 ●
社会福祉士国家試験受験基礎資格 ●
保育士 ●
社会調査士 ●
レクリエーション・インストラクター ●
本願寺派教師資格課程 ●●●●●●●●●●●●●●●●●●●●●●●●●●●●●●●●●
社会福祉主事任用資格 ●●●●●●●●●● ●●● ●●
児童指導員任用資格 ● ● ●●●
管理栄養士国家試験受験資格 ●
栄養士 ●
食品衛生管理者任用資格 ●
食品衛生監視員任用資格 ●
図書館司書課程
図書館などで資料の選択、収集、整理、情報 サービスなどを行う専門的職員をめざします。 指定科目の単位を修得し、卒業することで資格 取得が可能です。
学校図書館司書教諭課程
小学校・中学校・高等学校の図書館で専門的職 務に従事します。指定科目の単位を修得して教員 免許状を取得することで、資格が取得できます。
博物館学芸員課程
資料の収集・保管・展示および調査研究等の業 務に携わり、博物館の事業全般をサポートする学 芸員を養成します。
社会福祉士国家試験受験基礎資格 指定科目の単位を修得し、卒業後2年以上指定 された施設・事業・職種で実務経験を積むと、社 会福祉士国家試験の受験資格が取得できます。
認定心理士資格基礎課程
心理学の基礎的な資格である社団法人日本心理 学会の「認定心理士」に関する基礎課程です。規 定の単位を修得し卒業すると取得できます。
公認心理師受験資格課程
公認心理師は、特に保健医療や福祉分野における活 躍が期待されています。公認心理師の受験には、大学 での所定科目を履修後、大学院での所定科目の履修、 または大学卒業後2年以上の実務経験が必要です。
社会福祉士国家試験受験資格
専門的な知識や技能を用い、助言や指導等の援助 を行う福祉の専門職です。指定科目の単位を修得 すれば卒業後、国家試験受験資格が取得できます。
精神保健福祉士国家試験受験資格
精神障がいの被治療者、または関連施設の利用者 に対して各種の相談に応じ、助言、指導などを行 う専門職です。国家試験受験資格が取得できます。
社会福祉主事任用資格
福祉に関連する職場で、生活保護法、児童福祉法、 母子および父子並びに寡婦福祉法などに基づく援 護、育成または更生の措置に関する事務を行います。
保育士 保育所、乳児院、児童養護施設、知的障がい児施 設など児童福祉施設の職員に求められる資格で す。所定の単位の修得で国家資格が取得できます。
社会調査士(社会調査協会認定)
アンケートやインタビューなど、社会調査につい ての専門知識・技術を証明する資格。企業や官公 庁の調査部門などでの活躍が期待できます。
レクリエーション・インストラクター
余暇やレクリエーションに関する理論と実技を学 び、それを楽しく教える指導者として、地域を中心 に社会福祉や企業などあらゆる領域で活動します。
本願寺派教師資格課程
浄土真宗本願寺派教師(住職)になるための課 程です。当該課程の所定の科目を修得することで 本願寺派教師資格を得るための受験資格を取得 できます。
食品衛生監視員任用資格
食品に起因する食中毒や、食品衛生に関する危害 防止を目的に、食品を取り扱う施設への立ち入り 検査・指導を行う行政機関の職員をめざします。
児童指導員任用資格
児童養護施設において児童の生活指導を行うこ とを職務とします。
管理栄養士国家試験受験資格 病院・保健所・学校などの施設で献立づくりや、 栄養指導を行います。指定科目の単位を修得する ことで、国家試験受験資格が取得できます。
栄養士
栄養学の専門的な知識に基づいて、栄養バラン スの取れた献立の作成や調理方法の改善提案な ど、健康な食生活をアドバイスする専門職です。
食品衛生管理者任用資格 衛生上の配慮が求められる食品や添加物の製造・ 加工施設で健全に衛生が守られるよう、製造・加 工に従事する人を監督する業務です。
社会教育主事(任用資格) 社会教育を行う者に対する専門的技術的な助言・ 指導にあたる専門職です。指定科目の単位を修 得後、社会教育士(養成課程)を称することがで きます。指定科目の単位を修得し、卒業後社会教 育に関わる仕事を通算1年以上経験することで社 会教育主事になるための資格が得られます。
心理学部 文学部 経済 学部 経営学部 法学部政策学部 国際 学部 先端理工学部 社会学部農学部 短期 大学部 心理学科 真宗学科 仏教学科 哲学科歴史学科 日本語日本文学科英語英米文学科現代経済学科国際経済学科 経営学科 法律学科 政策学科 国際文化学科
図書館司書課程 ●●●●●●●●●●●●● 学校図書館司書教諭課程 ●●●●●●●●●●●●● 博物館学芸員課程 ●●●●●●●●●● ●●● ● ● 社会教育主事(任用資格) ●●● 認定心理士資格基礎課程 ● 公認心理師受験資格課程
Ryukoku University 2024 84
学部・学科・課程・専攻
取得できる教員免許状
学部・学科・課程・専攻 中学校教諭一種免許状高等学校教諭一種免許状その他免許状
心理学部 心理学科 公民
日本語日本文学科 国語 国語 英語英米文学科 英語 英語
経済学部 現代経済学科 社会 公民
国際経済学科 社会 地理歴史
経営学部 経営学科 社会 地理歴史・公民・商業
法学部 法律学科 社会 地理歴史・公民
政策学部 政策学科 社会 公民
国際学部 国際文化学科
英語 グローバルスタディーズ学科
先端理工学部
数理・情報科学課程
数学・情報 知能情報メディア課程 情報 電子情報通信課程 工業 機械工学・ロボティクス課程 工業 応用化学課程 理科 理科 環境生態工学課程 理科 理科
教職課程の履修には、別途、教職課程履修料(3万円)が必要です(短期大学部を除く全学部)。
小学校教諭免許状取得支援制度
卒業時に小学校教諭免許状を申請することができます。
龍谷大学在学中に、本学と協定を結んでいる大学の「通信教育課程特別科目等履修生」として、小学校教諭免許状取得に必要な単位を修得します。この制度を利用し必要単 位を修得することで、小学校教諭免許状を申請することができます。本学の学修に加え、自宅学習、スクーリング(協定を結ぶ大学での授業)および教育実習が必要となりま す。履修計画と教職をめざす強い意志をもって臨んでください。
※本制度を利用するためには、1年次に開催する説明会に参加し、本学において中学校教諭一種免許状または高等学校教諭一種免許状を取得する必要があります。 ※本制度参加人数は1学年50人。別途、協定を結ぶ大学の授業料(約50万円)が必要です。
宗教
哲学科
社会 地理歴史 歴史学科 東洋史学専攻 社会 地理歴史 歴史学科 仏教史学専攻 社会 地理歴史 歴史学科 文化遺産学専攻 社会 地理歴史
文学部 真宗学科
宗教 仏教学科 宗教 宗教
哲学専攻 社会 地理歴史・公民 哲学科 教育学専攻 社会 地理歴史・公民 歴史学科 日本史学専攻
英語
英語
英語
数学
社会 公民 現代福祉学科 社会
農学部 生命科学科 理科
農学科 理科
食品栄養学科
農業
Ryukoku University 2024 85
社会学部 社会学科 社会 地理歴史・公民 コミュニティマネジメント学科
公民
理科・農業
理科・農業
栄養教諭一種 食料農業システム学科
短期大学部 社会福祉学科 こども教育学科 幼稚園教諭二種
龍谷大学の課外活動
龍谷大学にはスポーツ・文化系をはじめ、宗教や各種委員会など 約85のクラブがあります。ほかにも深草・瀬田キャンパスには 合計100以上もの学生サークルがあり、個性的な活動を展開しています。 学生一人ひとりが、興味あること、得意なこと、好きなことに取り組み、
喜びを分かち合い、キャンパスライフを充実させています。

龍谷課外活動公式アプリ
各クラブのこれまでの活躍や試合予定、 基本情報(活動頻度・場所・SNS等)を掲載
Ryukoku Activities
Ryukoku University 2024 86

Ryukoku University 2024 87
Sports Ryukoku Activities







体育系課外活動

全国トップレベルのバドミントン部、柔道部をはじめ、計43団体、約 1,500名が日々活動をしています。スポーツを通じて、競技力の向上 だけでなく、人間的成長も図っています。また、大学スポーツを盛り上 げるため、吹奏楽部、バトン・チアSPIRITS、一般同好会の応援リー ダー部の連携による応援活動も活発に行っています。

Ryukoku University 2024 88
43 団体
● 柔道部
● 相撲部

● 剣道部
● 硬式野球部
● 端艇部
● 弓道部
● 卓球部
● ラグビー部
● 陸上競技部
● 自動車部
● バドミントン部
● 日本拳法部
● スキー部
● 合気道部
● サッカー部
体育局
● アイススケート部
● 硬式庭球部
● 洋弓部
● ソフトテニス部



● 山岳部
● ボクシング部
● 男子バスケットボール部
● 男子バレーボール部
● 少林寺拳法部


● フェンシング部
● ユースホステル部
● 空手道部
● 航空部
● 自転車部
● 女子バレーボール部
● 女子バスケットボール部
● アメリカンフットボール部
● ゴルフ部
● ソフトボール部
● ハンドボール部
● ヨット部
● 準硬式野球部
● バトン・チア SPIRITS
● ラクロス部
● 居合道部
● 水上競技部

Ryukoku University 2024 89
30 団体 学術文化局

● 能楽部
● 邦楽部
● 劇団未踏座
● 池坊華道部
● 龍吟会



● 落語研究会
● E.S.S.
● 書道部蟠龍會
● 美術部あーちすと会
● 写真部
● 映画研究部
● 文芸部
● 茶道部釣寂会
● 陶芸部
● フォークソング認定 同好会“黄色いトマト”
11 団体
[宗教局]
● 合唱団
● 宗教教育部
● 伝道部
● パイオニアクラブ
● 仏像研究会
● 仏教青年会
[放送局]
● 放送局
● 軽音楽部
● マンドリンオーケストラ
● 吹奏楽部
● 税務会計学研究会
● 経済研究会
● 広告研究会
● 心理学研究会
● 考古学研究会
● 古美術研究会
● 釣研究会
● 愛棋会
● ボランティアサークル
● 野外活動部
● 交響楽団
● プログラミング準認定 同好会Horizon
宗教・放送局 委員会
[委員会]
● 中央執行委員会
● 海外交流委員会
● 創立記念降誕会実行委員会
● 龍谷祭実行委員会

Ryukoku University 2024 90
Ryukoku Activities Culture



文化系課外活動
2022年度全日本吹奏楽コンクール 大学の部で13回目の金賞を受賞 した吹奏楽部をはじめ、学園祭(龍谷祭)の企画から実施を担う龍谷 祭実行委員会、親鸞聖人の教えを学び、建学の精神を広く発信するた



めの活動を行う宗教局まで、約40団体、約2,000名が、文化・芸術 等のさらなる発展に向けて、日々活動をしています。

Ryukoku Uni versity 2024 91
[深草キャンパス] スターバックスコーヒー
大学内にスターバックスコーヒーが併設。ス ターバックスのドリンクが豊かな学生生活を 後押ししてくれます。

Restaurant & Café Foods

学食&カフェ
龍谷大学では、各キャンパスにレストラン・Caféなどを展開しています。
各店舗ではそれぞれが特色のあるメニューを用意し、 健康で充実した学生生活をサポートしています。
[深草キャンパス]
Café Ryukoku
&
「食と人をつなぐ・人と人をつなぐ・人と地域 をつなぐ」をコンセプトに2020年4月にオー プン。野菜中心のランチは、手作りのドレッシ ングをかけてお召し上がりください。店内で 焼いたマフィンもおススメ。
Ryukoku University 2024 92
20種を超える小鉢から選べる、栄養バランス のよい和洋食スタイルです。


[深草キャンパス]
特製のコーヒーや焼きたてパンなどの軽食だ けでなく、定食、お弁当など充実したメニュー を味わうことができます。



[深草キャンパス]
3号館食堂
オムライスをはじめ、定食や石焼ビビンバな ど週替わりでバラエティに富んだメニューを 提供するフードコート形式の食堂です。



不二家食堂
龍谷大学オリジナルのパフェやワッフルなど スイーツメニューが充実しているカフェコー ナーです。
メニューの種類も豊富で、メインのおかずや 味噌汁、サラダに小鉢など、自分の好みで食 事を選べるだけでなく、毎日通っても飽きな いように期間限定メニューも豊富です。
[深草キャンパス]
4号館ミール&カフェ
コーヒーや紅茶、キャラメルマキアートをはじ め、クレープやオリジナルパフェなど、授業の 合間にくつろげるメニューが充実しています。
[瀬田キャンパス]
不二家食堂オムライス専門店
安い・おいしい・ボリューム満点なオムライス は大人気です。おしゃべりをしながらくつろげ る空間で、晴れた日はオープンテラスで食事 することもできます。
 [深草・瀬田・大宮キャンパス] 生協食堂
[瀬田キャンパス] パフェ工房
[瀬田キャンパス]
[深草・瀬田・大宮キャンパス] 生協食堂
[瀬田キャンパス] パフェ工房
[瀬田キャンパス]
カフェ樹林 Ryukoku University 2024 93
学費等について
2024(令和6)年度入学者の学費および諸会費の予定額は以下のとおりです。
2024年度学費は9月頃に決定いたします。決定後の金額につきましては、2024入学試験要項(9月頃発行)、または龍谷大学Webサイト「入試情報」をご確認ください。
第1年次納入金総額
(①第1年次学費と②第1年次諸会費の合計)
注:諸会費の内訳について
諸会費は、学会、学友会、親和会、校友会からの委託徴収金です。
各学部等には、それぞれの学術研究の推進のために、専任教員、大学院生、学部学生等で 構成する学会を設けています。その学会の会費として、入会金2,000円(経営学部・社会 学部・農学部を除く)、学会費[心理学部 文学部・経済学部・経営学部・先端理工学部・ 農学部・短期大学部はそれぞれ年間3,000円(前期1,500円、後期1,500円)、法学部・政策 学部・国際学部・社会学部はそれぞれ年間4,000円(前期2,000円、後期2,000円)]を納入 していただきます。
学友会はすべての学生によって構成され、学生の声を反映させながら学生生活の改善・ 向上に取り組んでいる学生自治会です。その会費として、入会金4,500円、学友会費
※1: ※2: 入学金は入学年度のみ納入していただきます。
授業料は、入学時の学費負担軽減を図るため、入学初年度(1年次)は、年間260,000円 を減免しています。
年間3,500円(前期1,750円、後期1,750円)を納入していただきます。
親和会は、学生の保護者をもって構成され、龍谷大学の発展に資し、あわせて会員相互の 親睦を図ることを目的としています。その会費として、入会金3,000円、親和会費年間 7,000円(前期3,500円、後期3,500円)を納入していただきます。
校友会は、龍谷大学および龍谷大学短期大学部を卒業した人等で、組織されています。 終身会費として、40,000円納入していただくことが必要ですが、この会費のうち、 10,000円を入学時に予納していただきます。残額については、卒業年次に納入して いただきます。
※3: ※4: 授業料は、短期大学部の場合、入学時の学費負担軽減を図るため、入学初年度(1年次) は、年間360,000円を減免しています。
文学部歴史学科文化遺産学専攻は実習料として、前期17,950円、後期17,950円を納入 していただきます。
① ② ③
④ ⑤
学 部 政策学部 国際学部 社会学部 国際文化学科 食品栄養学科 グローバル スタディーズ学科 短期大学部 社会福祉学科 こども教育学科 先端理工学部 数理・情報 科学課程 数理・情報 科学課程以外 食料農業 システム学科 農学部 生命科学科 農学科 入学金※1 400,500円400,500円 418,450円 428,000円485,500円 398,000円413,000円 574,500円599,500円 574,500円589,500円499,500円 前期授業料※2※3 ー7,500円 27,450円27,450円 71,800円 71,800円 96,800円17,950円 71,800円 前期実験実習料・実習料 1,061,000円1,076,000円 1,096,900円 1,116,000円1,431,000円 1,110,900円1,140,900円 1,602,600円 1,552,600円 1,632,600円1,294,900円 1,552,600円 合計(初年度納入金) ー100,000円 前期留学実習料 400,500円400,500円 418,450円 428,000円485,500円 398,000円413,000円 599,500円 574,500円 589,500円499,500円 574,500円 後期授業料※2※3 ー7,500円 27,450円27,450円 71,800円 71,800円 96,800円17,950円 71,800円 後期実験実習料・実習料 660,500円668,000円 678,450円 688,000円845,500円 685,450円700,450円 931,300円 906,300円 946,300円777,450円 906,300円 小計(入学時納入金) ー100,000円 後期留学実習料 400,500円 心理学部 260,000円 503,500円 1,267,000円 503,500円 763,500円 503,500円 408,000円 418,450円 428,000円585,500円 425,450円440,450円 671,300円 646,300円 686,300円517,450円 646,300円 小計(後期納入金) ① 第1年次学費 260,000円260,000円 260,000円 260,000円260,000円 260,000円260,000円 260,000円260,000円 260,000円260,000円260,000円 文学部※4 経済学部 経営学部 法学部 687,250円 1,095,000円 407,750円 694,750円 1,110,000円 415,250円 714,750円 1,150,000円 435,250円 872,250円 1,465,000円 592,750円 932,550円 1,585,600円 653,050円 957,550円 1,635,600円 678,050円 703,200円 1,128,900円 425,700円 930,550円 1,583,600円 653,050円 970,550円 1,663,600円 693,050円 801,700円 1,325,900円 524,200円 711,700円 1,143,900円 432,200円 726,700円 1,173,900円 447,200円 政策学部 国際学部 社会学部 国際文化学科 食品栄養学科 グローバル スタディーズ学科 短期大学部 社会福祉学科 こども教育学科 先端理工学部 数理・情報 科学課程 数理・情報 科学課程以外 食料農業 システム学科 農学部 生命科学科 農学科 法学部 684,750円 1,092,000円 407,250円 経営学部 入学時納入金合計 合計(初年度納入金) 後期納入金合計 686,750円 1,094,000円 407,250円 学 部 文学部※4 経済学部 789,750円 1,300,000円 510,250円 心理学部 注:後期納入金に関する納入期日等の詳細については、入学後に経理課からご案内いたします。 26,250円 6,750円 33,000円 26,250円 6,750円 33,000円 26,250円 6,750円 33,000円 24,250円 6,750円 31,000円 24,250円 6,750円 31,000円 24,250円 6,750円 31,000円 26,250円 6,750円 33,000円 26,250円 6,750円 33,000円 24,750円 7,250円 32,000円 24,250円 6,750円 31,000円 26,750円 7,250円 34,000円 26,750円 7,250円 34,000円 26,750円 7,250円 34,000円 食品栄養学科 社会福祉学科 食料農業 システム学科 生命科学科 農学科 ② 第1年次諸会費 諸会費(入学時納入金) 諸会費(後期納入金) 合計(初年度納入金) 学 部 経営学部 国際学部 社会学部 国際文化学科 グローバル スタディーズ学科 短期大学部 こども教育学科 先端理工学部 数理・情報 科学課程 数理・情報 科学課程以外 農学部 心理学部 文学部 経済学部 政策学部 法学部 Ryukoku University 2024 94
奨学金制度
詳細はこちらをご覧ください。 [奨学金Webサイト]
龍谷大学では、独自の奨学金制度を設け、経済的なサポートを充実させており、多くの学生に奨学金を給付しています。下記奨学金制度以 外にも、留学に関する奨学金制度や保護者会組織、日本学生支援機構、地方公共団体・民間団体が実施する奨学金制度も利用できます。
ひとり暮らしを始める者への奨学金 ひとり暮らし支援奨学生
学業成績優秀者への奨学金
アカデミック・スカラシップ奨学生 (在学採用型)
スポーツ・課外活動などの成績優秀者への奨学金 優秀スポーツ選手奨学生(推薦制) 課外活動等奨学生(推薦制)
○年額 20 万円 ※ 全学部共通 入学時 (出願時にエントリー)
○年額 20 万円
※ 全学部共通
○ S給付 年間学費相当額の範囲内
※ 優秀スポーツ選手奨学生のみ
○ A給付 50 万円の範囲内
○ B給付 20 万円の範囲内
○ C給付 10 万円の範囲内
※ 全学部共通
経済的理由により、修学が困難な者への奨学金 家計奨学生
○年額 35 万円・25 万円または 15 万円 ※ 全学部共通
大学進学にともない、ひとり暮らしを始める者 のうち、経済的理由により修学が困難であると 認められる者。 ※詳細については、「入試ガイド」または 9月発行予定の「入学試験要項」をご確認ください。
2年次から 4年次 2年次以降、優秀な成績を修めた者。
2年次から 4年次 学業とスポーツ活動または課外活動などに おいて、積極的に取り組む強い意志が確認 できる者。
1年次から 4年次 (1人につき 1回のみ給付)
家計が急変し、修学が困難な者への奨学金 家計急変奨学生
自然災害の被災により、修学が困難な者への奨学金 災害学費援助奨学生
災害被災者を対象に、受験料減免の制度も設けています。
○心理学部、先端理工学部、農学部、 国際学部 グローバルスタディーズ学科 40 万円の範囲内 ○上記以外の学部、短期大学部 30 万円の範囲内
1年次から 4年次 (1人につき 1回のみ給付)
修学の意志があるにもかかわらず、経済的 な理由により修学が困難である者。
家計支持者が自己都合(退職・転職など)以外 の何らかの事由により、収入が減少し、学費 支弁が困難となった者。
被災内容に応じて、年間授業料相当額ま たは半期授業料相当額を給付。
※ 全学部共通
入学時 (出願締切前 までに申請)
入学試験に合格し本学に入学する者で、自然 災害などによる災害救助法適用地域に本人ま たは父母(または家計支持者)のいずれかが 居住しており、学費支弁が困難となった者。
災害給付奨学生
災害規模に応じて別途、特別援助奨学金を設ける場合があります。
被災内容に応じて、年間授業料相当額ま たは半期授業料相当額を給付。
※ 全学部共通
1年次から 4年次
自然災害等による被害を受けた地域に本人ま たは父母(または家計支持者)のいずれかが 居住しており、学費支弁が困難となった者。 親
龍谷大学親和会は、龍谷大学に在籍する学生の保護者によって組織・構成されている団体で、いわゆる保護者会です。親和会は、全国の大学に先駆けて 1962年に設立され、約60年にわたって活動を続けています。学生が、悔いのない有意義な学生生活を送れるように、保護者の立場から支援を行っていく こと、また、保護者相互の交流を図り親睦を深めていくことを目的としています。親和会は、大学と家庭とを結ぶパイプの役割を担いながら、大学の発展・ 向上を共にめざすため、学生・大学に対しさまざまな支援活動を行っています。
主な保護者 対象事業
主な学生・大学 支援事業
全国保護者懇談会の開催 (大学と共催)
保護者のみなさまと教職員が懇談する「全国 保護者懇談会」を大学と連携して全国29会場 で開催しています。
広報関連事業 「親和会だより」の発行
年2回、大学広報誌「広報『龍谷』」の発刊時 期にあわせ親和会向け情報冊子(本学の最新 情報、親和会事業など)を発行しています。
親和会では、学生の活動に対する各種奨学金制度のほか、 大学の取り組みに対して助成活動を行っています。
主な奨学金制度、助成活動は右記のとおりです。
● 親和会海外研修奨学金制度 (夏期・春期の年2回)
● 親和会学生活動奨励金制度
三者(大学・親和会・校友会)
共催事業の開催
大学・親和会・校友会(卒業生組織)の三者によっ て、大学懇談会、龍谷大学ホームカミング・デー(学 園祭と同時開催)などの事業を実施しています。
● 親和会自然災害等特別見舞金制度
● 教育・研究活動助成制度/特別助成制度
● 課外活動・健康診断・就職支援・宗教教育・ スクールバスへの助成 など
主な制度 奨学金額 給付対象の時期 対 象
わ 会 かい
しん 和
(龍谷大学保護者会組織)
● 親和会学生救済型奨学金制度 Ryukoku University 2024 95
学生寮
龍谷大学 専用学生寮(Ryukoku Student Home 光輝)
深草キャンパスまで徒歩約8分。
食事付き、家具家電備え付けの学生寮
2022年春、深草キャンパスから徒歩8分の好立地に龍谷大学 専用学生寮「Ryukoku Student Home 光輝」が誕生しました。

食事付き(選択制)・家具家電備え付けで、寮長寮母も住み込みのためセキュリティも万全です。
居室設備
机・イス/すのこベッド/Wi-Fi/シューズBOX/洗面化粧台/ 電気スタンド/カーテン/クローゼット/本棚/エアコン/照明器具/ テレビ端子/トイレ(温水洗浄付)/2ドア冷蔵庫/バス内乾燥機/ バス・トイレセパレート/洗濯機/電子レンジ
共用設備
ダイニングルーム/シェアキッチン/シアタールーム/ スタディルーム/複合機/コーヒーマシン/テラス/シェアサイクル/
駐輪場/宅配BOX/メールBOX/エレベーター
共用備品
AED/アイロン/掃除機
Ryukoku Student Home 光輝






京都市伏見区深草西浦町8丁目67番
● 地下鉄「くいな橋」駅 徒歩約10分
● 京阪本線「藤森」駅 徒歩約12分
● 京阪本線「龍谷大前深草」駅 徒歩約10分
★深草キャンパスまで:徒歩約8分
● 2022年3月完成
● 男子・女子寮
● 食事付き(選択制)
● 寮長寮母住み込み
マンション名 所在地/アクセス
ポイント
龍谷 寮
Ryukoku University 2024 96
ドーミー京都くいな橋
京都市伏見区竹田七瀬川町15-12
● 近鉄京都線・地下鉄烏丸線「竹田」駅 徒歩約5分
● 京阪本線「藤森」駅 徒歩約13分
★深草キャンパスまで:自転車約5分(1,200m)
京都市伏見区竹田中島町234番地
● 市営地下鉄烏丸線「くいな橋」駅 徒歩約5分
● 近鉄京都線「竹田」駅 徒歩約8分
● 京阪本線「龍谷大前深草」駅 徒歩約15分
★深草キャンパスまで:徒歩約8分
キャンパスヴィレッジ 京都伏見
京都市伏見区竹田北三ツ杭町24-1
● 地下鉄烏丸線「くいな橋」駅 徒歩約4分
● 近鉄京都線「竹田」駅 徒歩約7分
★深草キャンパスまで:自転車約5分(1,050m)
クレスト草津
滋賀県草津市笠山5丁目3番27号

● JR東海道線「南草津」駅 自転車13分(3,100m)
● 近江バス「クレスト草津前」停 徒歩1分
★瀬田キャンパスまで:自転車13分(3,200m)
ドーミー桃山御陵
京都市伏見区京町4-144
● 近鉄京都線「桃山御陵前」駅 徒歩約1分
● 京阪本線「伏見桃山」駅 徒歩約1分
ドーミー清水五条
京都市東山区大黒町通り五条下ル1丁目袋町285番
● 京阪本線「清水五条」駅 徒歩約3分
● 市バス「五条大和大路」停留所 徒歩約1分

ドーミー京都山科
京都市山科区竹鼻竹ノ街道町24
● 市営地下鉄東西線「山科」駅 徒歩約1分
● JR東海道線「山科」駅 徒歩約4分
● 京阪電鉄京津線「山科」駅 徒歩約4分
★瀬田キャンパス・深草キャンパスにも通学便利
● 2022年3月完成
● 男子・女子寮
● 食事付き(選択制)
● インターネット無料
● 管理人駐在(平日9-17時)
● 女子寮
● 2021年春完成
● 食事付き(選択制)
● 3路線利用可能な好立地
● 男子・女子寮(女子専用フロア)
● 2020年3月完成
● 食事付き(選択制)
● インターネット無料
● 管理人駐在(平日9-17時)
● 女子優先棟
● 学生専用マンション

● 管理人駐在(平日9-17時)
● コンビニ徒歩約3分
● 男子・女子寮
●食事付き(選択制)
● 大手筋商店街すぐ
● 男子・女子寮
● 食事付き(選択制)
● 清水寺に近い「京焼の街」に2015年春オープン!
● 2022年春完成
● 男子・女子寮
● 食事付き(選択制)
S-RESIDENCE 京都竹田 dormitory ドーミー京都くいな橋 クレスト草津 龍谷大学
マンション名 所在地/アクセス ポイント
京都竹田 dormitory
推奨寮
S-RESIDENCE
Ryukoku University 2024 97
その他の施設
深草町家キャンパス 成就館
幕末に建築された京町家で、地域交流、異文化交流、アクティブラーニングを展開 学生の活動拠点として賑わう地域にも開かれた施設

深草町家キャンパスは、地域住民が親しみをもちやすい「町家」を活 用した龍谷大学の施設です。学生・教員と地域住民との協働活動・ 交流の場としての活用をはじめ、大学・大学院の演習教室、サークル 活動の稽古場や成果発表の場としての役割も果たしています。施設

は、1861(文久元)年建築の木造2階建ての京町家を改修したもの で、京都市が全国初の条例として制定した「京都市歴史的建築物の 保存及び活用に関する条例」の適用第1号として保存建築物に登録 されています。
成就館は正課および課外活動の活性化、学生生活の充実、研究の発 展に寄与する施設です。350名収容可能なメインホール「Ryukoku Main Theater」や少人数の報告会などに利用できる「Ryukoku Live Theater」、和室や展示会に使用できるスペースなど、さまざま

な用途にあわせて利用できます。課外活動の場として賑わうほか、誰 でも利用可能なカフェダイニングを備え、学生と地域住民の交流の場 としての役割も担っています。

Ryukoku University 2024 98
RECホール

龍谷大学の研究と教育を 広く社会に発信し、地域社会に貢献


大学の研究や教育、人材など資源のエクステンション(普及)活動を担 う地域連携の拠点として開設しました。多彩な教員による、地域社会や 企業を対象とした研究開発・マネジメント支援といった産官学連携事業、 地域住民に学習の機会を提供する生涯学事業のほか、地域連携事業、 施設開放事業、学生ベンチャー育成事業などを展開しています。
龍谷ミュージアム
仏教をわかりやすく紹介する
仏教総合博物館
京都駅から徒歩約12分、世界文化遺産・西本願寺の向かい側にある仏 教総合博物館です。特別展やシリーズ展などを年間を通じて開催してい ます。特別展では特定のテーマを設け、さまざまな角度から仏教を紹介 し、シリーズ展では仏教の誕生から現代までの仏教の広がりを「アジアの 仏教」と「日本の仏教」に分けて紹介します。NHKと龍谷大学の共同プ ロジェクトとして制作した仏教壁画の高精細デジタル復元は必見です。
矯正・保護総合センター
龍谷大学農学部 牧農場・堂農場
本センターは、龍谷大学にしかない日本で唯一のセンターです。犯罪や 少年非行を中心としつつ、広く真宗学、法学、社会学、政策学、心理学、 福祉学、教育学、医学などの分野に関わり、学際的に教育や研究、社会 貢献の活動をしています。特に教育活動では、矯正・保護課程を運営し、 特別研修講座として多くの科目を全学に提供しています。このほか、セン ターではいくつかの研究プロジェクトを所管し、犯罪や非行を犯した人の 立ち直りを中心に、国際的な研究活動を遂行しています。
米や野菜を栽培する農作業を体験し 農場の持続的な循環について学ぶ
農学部では、瀬田キャンパスの近くに、約2.7haの実習用の牧農場 と、研究用 圃 ほじょう 場 の堂農場を有しています。牧農場では、1・2年次全 員が「食の循環実習」をとおして、牧農場で田植えなどの農作業を体 験。米・麦・大豆や、季節ごとの野菜などを栽培し、実際の農地での 学びに触れることで「食」と「農」への理解を深めます。堂農場では、 研究室に配属された3年次以上の学生と教員がそれぞれ特徴ある研 究を進めています。

教育・研究・社会連携に関わる 総合的な取り組みを実施
Ryukoku University 2024 99
Access Guide
近鉄南大阪線
龍谷 京阪バス
School Bus

キャンパス間の移動が簡単。
瀬田 深草キャンパス間を スクールバスが運行中。
課外活動等、キャンパス間の 移動が可能です。
JR「京都」駅までの乗車時間(分) 京阪本線「龍谷大前深草」駅までの乗車時間(分) JR「京都」駅までの乗車時間(分)
駅名に付記した時間は、JR「京都」駅、京阪本線「龍谷大前深草」駅までの最短乗車時間の目安を記しています。 乗り換え等にかかる時間は含んでいません。また、時間帯によって変わることがありますのでご注意ください。
瀬田キャンパスへの通学はJR新快速と直通バスが便利
京都・大阪・兵庫方面からのアクセスがJR新快速利用により便利で快適です。
さらにJR「大津」駅と京阪「中書島」駅からは、瀬田キャンパス直通バスの利用が便利です。
稲荷駅下車、南西へ徒歩8分
龍谷大前深草駅下車、西へ徒歩3分
JR東海道本線・近鉄京都線 京都駅下車、徒歩10分 JR山陰本線(嵯峨野線)梅小路京都西駅下車、徒歩10分 阪急京都線 大宮駅より市バス乗車約5 ぐす車下」宮大条七「、分
JR 「大津」駅
中書島駅下車、京阪京都交通バス30分
JR線 新幹線 近畿日本鉄道 阪急電鉄 南海電鉄
駅名 駅名 神戸電鉄 神戸市営地下鉄 北神急行電鉄 近江鉄道 京阪電鉄 京都市営地下鉄 大阪メトロ 阪神電鉄 神戸高速鉄道 近江鉄道 バス・徒歩 大阪モノレール 徒歩 約10分 徒歩 約7分 徒歩 約3分 徒歩 約8分 バス約5分 山陽新幹線 神戸電鉄三田線 北神急行電鉄 阪神本線 南海本線 近鉄奈良線 近鉄京都線 京阪本線 阪神なんば線 JR神戸線 JR琵琶湖線 JR草津線 JR湖西線 JR山陰本線(嵯峨野線) JR 大阪環状線 JR大和路線 JR学研都市線 JR奈良線 阪急神戸線 阪急京都線 阪急嵐山線 京都市営地下鉄東西線 京都市営地下鉄 烏丸線 神戸三宮 三宮 西宮北口 神戸三宮 尼崎 王寺 宇治 生駒 放出 六地蔵 十三 谷上 横山 太秦天神川二条 三条(三条京阪) 嵯峨嵐山 烏丸御池 京都河原町 くいな橋 大宮 桂 箕面 伊丹 嵐山 大宮 深草 大津 膳所 近江塩津 山科 堅田 近江今津 彦根 近江八幡 貴生川 敦賀 竹田 中書島 烏丸 (四条) 国際会館 北大路 梅田 西九条 西宮 大阪 高槻 草津 近鉄奈良 奈良 枚方市 淀屋橋 丹波橋 瀬田 バス約8分 バス約20分 琵琶湖 瀬田 鶴橋 4245 園四条 木津 藤井寺 森ノ宮 天下茶屋 梅小路京都西 千里中央 新神戸 大和西大寺 39 JR福知山線 なんば 37 京橋 明石 68 41 28 12 21 44 3146 95 2723 大和八木 6358 4440 17 35 3538 約 30分 所要時間 詳しくはWebで 京阪本線 中書島駅発着 瀬田キャンパス直通バス 龍谷大前深草 近鉄大阪線 東海道新幹線 JR おおさか東線 丹波口 出町柳 大阪 梅田 42 天王寺 大阪梅田 JR 京都線 三ノ宮 50 阪急宝塚線 三田 74 宝塚 54 新大阪 24 京都 大阪メトロ 御堂筋線 尼崎 35 米原 53 神戸高速鉄道 大阪モノレール 国道1号線 JR琵琶湖線 びわこ文化公園都市 京滋バイパス 瀬田 瀬田キャンパス 名神高速道路 JR東海道新幹線 り 通 園 学
京阪本線
JR琵琶湖線 瀬田駅下車、帝産バス約8分 JR琵琶湖線 大津駅下車、近江鉄道バス約20分
京阪本線 七条駅下車、徒歩20分 線 本 阪 京 線 丸 烏 鉄 下 地 JR ︶ 線 野 峨 嵯 ︵ 線 本 陰 山 近鉄京都線 七条通 五条通 四条通 JR東海道本線 JR東海道新幹線 条 七 通 川 堀 通 宮 大 条 四 園 条 五 条 四 通 丸 烏 口 波 丹 京都 河原町 烏丸 大宮 阪急 京都線 京福電鉄 龍谷ミュージアム 宮 大 条 四 大宮 キャンパス 京 都 梅小路京都西 JR奈良線
京阪本線
京都市営地下鉄烏丸線
線 本 阪 京 田 竹 橋 な い く 線 丸 烏 鉄 下 地 線 都 京 鉄 近 荷 稲 荷 稲 見 伏 森 藤 JR 線 良 奈 法務局出張所 龍谷大前 京都府警察学校 紫光館 道 国 24 線 号 深草キャンパス 名神高速道路
瀬田キャンパス 約 60 分 (新快速利用) JR「三ノ宮」駅 約 60 分 (快速・特急利用 京都駅経由) JR・近鉄「奈良」駅 約 40 分 (新快速利用) JR「大阪」駅 約 10 分 (新快速利用) JR「京都」駅 バス(直行便) 約 20 分 JR「大津」駅前発着直通バス(授業期間中は常時運行) Otsu station Seta campus 20 min Ryukoku University 2024 100
くいな橋駅下車、東へ徒歩7分
阪急宝塚線 新大阪 24 大阪メトロ 御堂筋線
瀬田 深草キャンパス間を スクールバスが運行中。
南海電鉄
大阪梅田
深草キャンパス
(京都市)
JR「大阪」駅 → 約 42 分
京阪「京橋」駅 → 約 41 分
近鉄「奈良」駅 → 約 43 分
JR「三ノ宮」駅 → 約 63 分
近鉄南大阪線
大宮キャンパス
(京都市)
龍谷 京阪バス
中書島駅発着 大阪 梅田 42 天王寺
課外活動等、キャンパス間の 移動が可能です。
School Bus
JR「京都」駅までの乗車時間(分) 京阪本線「龍谷大前深草」駅までの乗車時間(分) JR「京都」駅までの乗車時間(分)
JR「大阪」駅 → 約 38 分
JR「天王寺」駅 → 約 52 分
近鉄「奈良」駅 → 約 54 分
JR「三ノ宮」駅 → 約 60 分
稲荷駅下車、南西へ徒歩8分
龍谷大前深草駅下車、西へ徒歩3分
くいな橋駅下車、東へ徒歩7分
瀬田キャンパス
JR「京都」駅 → 約 30 分
JR「大阪」駅 → 約 60 分
JR「天王寺」駅 → 約 67 分
線 本 阪 京 線 丸 烏 鉄 下 地 JR 線 野 峨 嵯 ︵ 線 本 陰 山 近鉄京都線 七条通 五条通 四条通 JR東海道本線 JR東海道新幹線 条 七 通 川 堀 通 宮 大 条 四 園 条 五 条 四 通 丸 烏 口 波 丹 京都 河原町 烏丸 大宮 阪急 京都線 京福電鉄 龍谷ミュージアム 宮 大 条 四 大宮 キャンパス 京 都 梅小路京都西 龍谷大前深草駅下車、西へ徒歩3分 くいな橋駅下車、東へ徒歩7分 荷 稲 森 藤 JR 線 良 奈 名神高速道路
JR「三ノ宮」駅 → 約 80 分
南海電鉄 駅名に付記した時間は、JR「京都」駅、京阪本線「龍谷大前深草」駅までの最短乗車時間の目安を記しています。 乗り換え等にかかる時間は含んでいません。また、時間帯によって変わることがありますのでご注意ください。
キャンパス間の移動が簡単。
瀬田 深草キャンパス間を スクールバスが運行中。
課外活動等、キャンパス間の 移動が可能です。
JR「京都」駅までの乗車時間(分) 京阪本線「龍谷大前深草」駅までの乗車時間(分) JR「京都」駅までの乗車時間(分) JR おおさか東線
JR奈良線「稲荷」駅下車、南西へ徒歩 約8分/京阪本線「龍谷大前深草」駅 下車、西へ徒歩約3分/京都市営地下 鉄烏丸線「くいな橋」駅下車、東へ徒 歩約7分
JR東海道本線・近鉄京都線 京都駅下車、徒歩10分
JR山陰本線(嵯峨野線)梅小路京都西駅下車、徒歩10分
阪急京都線 大宮駅より市バス乗車約5 ぐす車下」宮大条七「、分


京阪本線 七条駅下車、徒歩20分
JR東海道本線・近鉄京都線「京都」駅 下車、北西へ徒歩約10分/JR山陰本 線(嵯峨野線)「梅小路京都西」駅下車、 北東へ徒歩約10分/阪急京都線「大 宮」駅より市バス乗車約5分、「七条大 宮」下車すぐ/京阪本線「七条」駅下 車、西へ徒歩約20分
京阪本線 中書島駅下車、京阪京都交通バス30分 JR琵琶湖線 瀬田駅下車、帝産バス約8分
JR琵琶湖線 大津駅下車、近江鉄道バス約20分
瀬田 瀬田キャンパス
京滋バイパス
名神高速道路 JR東海道新幹線 り 通 園 学
尼崎 35 国道1号線 JR琵琶湖線 びわこ文化公園都市
京阪本線 中書島駅下車、京阪京都交通バス30分 JR琵琶湖線 瀬田駅下車、帝産バス約8分 JR琵琶湖線 大津駅下車、近江鉄道バス約20分
JR琵琶湖線「大津」駅下車、近江鉄道 バス約20分/京阪本線「中書島」駅下 車、京阪京都交通バス約30分/JR琵琶 湖線「瀬田駅」下車、帝産バス約8分
Topics
京阪「中書島」駅 瀬田キャンパス 京阪「京橋」駅 約 30 分 (特急利用) 京阪「寝屋川市」駅 約 29 分 (普通・準急(乗継)特急利用) 京阪「出町柳」駅 約 17 分 (特急利用) 約 30 分 バス(直行便)
Chusyojima station Seta campus 30 min Ryukoku University 2024 101
京阪「淀屋橋」駅 約 40 分 (特急利用) 京阪「枚方市」駅 約 15 分 (特急利用) 京阪本線 JR琵琶湖線 JR琵琶湖線 JR東海道本線・近鉄京都線 京都駅下車、徒歩10分 JR山陰本線(嵯峨野線)梅小路京都西駅下車、徒歩10分 阪急京都線 大宮駅より市バス乗車約5 ぐす車下」宮大条七「、分 京阪本線 七条駅下車、徒歩20分 線 本 阪 京 線 丸 烏 鉄 下 地 JR 線 野 峨 嵯 線 本 陰 山 近鉄京都線 七条通 五条通 四条通 JR東海道本線 JR東海道新幹線 条 七 通 川 堀 通 宮 大 条 四 園 条 五 条 四 通 丸 烏 口 波 丹 京都 河原町 烏丸 大宮 阪急 京都線 京福電鉄 龍谷ミュージアム 宮 大 条 四 大宮 キャンパス 京 都 梅小路京都西 JR奈良線 稲荷駅下車、南西へ徒歩8分 京阪本線 龍谷大前深草駅下車、西へ徒歩3分 京都市営地下鉄烏丸線 くいな橋駅下車、東へ徒歩7分 田 竹 橋 な い く 線 丸 烏 鉄 下 地 線 都 京 鉄 近 荷 稲 荷 稲 見 伏 森 JR 線 良 奈 法務局出張所 京都府警察学校 紫光館 道 国 24 線 号 深草キャンパス 名神高速道路
近鉄南大阪線
JR線 新幹線
近畿日本鉄道 阪急電鉄
駅名 駅名 神戸電鉄 神戸市営地下鉄 北神急行電鉄 京阪電鉄 京都市営地下鉄 大阪メトロ 阪神電鉄 神戸高速鉄道 近江鉄道 バス・徒歩 南海本線 近鉄奈良線 JR 大阪環状線 JR大和路線 王寺 生駒 西九条 近鉄奈良 奈良 鶴橋 4245 藤井寺 天下茶屋 大和西大寺 39 なんば 37 44 大和八木 6358 4440 35 近鉄大阪線 42 天王寺 大阪メトロ 御堂筋線 大阪モノレール 国道1号線 JR琵琶湖線 びわこ文化公園都市 京滋バイパス 瀬田 瀬田キャンパス 名神高速道路 JR東海道新幹線 り 通 園 学
線 本 阪 京 線 丸 烏 鉄 下 地 JR 線 野 峨 嵯 ︵ 線 本 陰 山 近鉄京都線 七条通 五条通 四条通 JR東海道本線 JR東海道新幹線 条 七 通 川 堀 通 宮 大 条 四 園 条 五 条 四 通 丸 烏 口 波 丹 京都 河原町 烏丸 大宮 阪急 京都線 京福電鉄 龍谷ミュージアム 宮 大 条 四 大宮 キャンパス 京 都 梅小路京都西 JR奈良線
線 本 阪 京 田 竹 橋 な い く 線 丸 烏 鉄 下 地 線 都 京 鉄 近 荷 稲 荷 稲 見 伏 森 藤 JR 線 良 奈 法務局出張所 龍谷大前 京都府警察学校 紫光館 道 国 24 線 号 深草キャンパス 名神高速道路
京阪本線
京都市営地下鉄烏丸線
駅名 駅名 神戸電鉄 神戸市営地下鉄 北神急行電鉄 大阪メトロ 阪神電鉄 神戸高速鉄道 バス・徒歩 大阪モノレール 徒歩 約7分 徒歩 約3分 約8分 近鉄奈良線 近鉄京都線 京阪本線 JR JR大和路線 JR学研都市線 JR奈良線 西宮北口 尼崎 王寺 宇治 生駒 放出 六地蔵 十三 くいな橋 伊丹 深草 竹田 中書島 梅田 西九条 大阪 高槻 近鉄奈良 奈良 枚方市 淀屋橋 丹波橋 瀬田 バス約20分 鶴橋 4245 木津 藤井寺 森ノ宮 天下茶屋 千里中央 大和西大寺 39 なんば 37 京橋 28 12 44 3146 95 2723 大和八木 6358 4440 35 3538 約 30分 所要時間 詳しくはWebで 京阪本線
駅名に付記した時間は、JR「京都」駅、京阪本線「龍谷大前深草」駅までの最短乗車時間の目安を記しています。 乗り換え等にかかる時間は含んでいません。また、時間帯によって変わることがありますのでご注意ください。 瀬田キャンパス直通バス 龍谷大前深草 近鉄大阪線
JR東海道本線・近鉄京都線 京都駅下車、徒歩10分 JR山陰本線(嵯峨野線)梅小路京都西駅下車、徒歩10分 阪急京都線 大宮駅より市バス乗車約5 ぐす車下」宮大条七「、分 京阪本線 七条駅下車、徒歩20分
(滋賀県大津市)
京阪「中書島」駅前発着直通バス(授業期間中は常時運行)
■ 心理学部
心理学科
■ 文学部
真宗学科/仏教学科/哲学科 哲学専攻・教育学専攻/
歴史学科 日本史学専攻・東洋史学専攻・仏教史学専攻・文化遺産学専攻/ 日本語日本文学科/英語英米文学科
■ 経済学部
現代経済学科/国際経済学科

■ 経営学部 経営学科
■ 法学部 法律学科
■ 政策学部 政策学科
■ 国際学部 グローバルスタディーズ学科/国際文化学科
■ 先端理工学部 数理・情報科学課程/知能情報メディア課程/電子情報通信課程/ 機械工学・ロボティクス課程/応用化学課程/環境生態工学課程
■ 社会学部 社会学科/コミュニティマネジメント学科/現代福祉学科
■ 農学部 生命科学科/農学科/食品栄養学科/食料農業システム学科
■ 短期大学部 社会福祉学科/こども教育学科
2023年4月発行 ※掲載の学年、所属などは取材時のものです。 龍谷大学 入試部 〒612-8577 京都市伏見区深草塚本町67 0570-017887(ナビダイヤル) https://www.ryukoku.ac.jp/admission/ LINE ryukoku_nyushi1639 Twitter ryukoku_nyushi 龍谷大学受験生向けアプリ ru navi Instagram ryukokuuniversity
Facebook

[深草・瀬田・大宮キャンパス] 生協食堂
[瀬田キャンパス] パフェ工房
[瀬田キャンパス]
[深草・瀬田・大宮キャンパス] 生協食堂
[瀬田キャンパス] パフェ工房
[瀬田キャンパス]



















